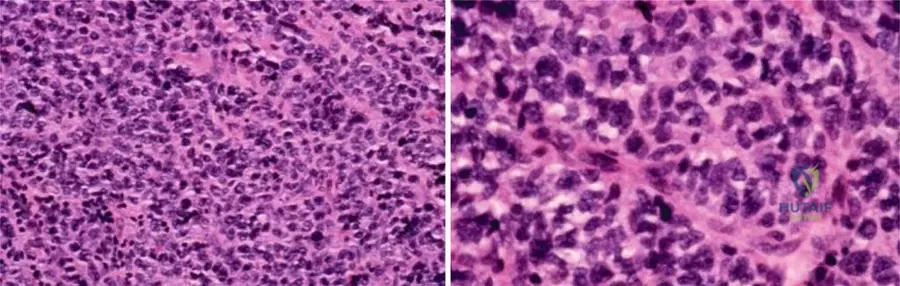

Master ABOS Orthopedic Pathology & Skeletal Dysplasia Review | Part 10

Key Takeaway
This ABOS board review section covers key orthopedic pathology topics including benign and malignant bone tumors like enchondromas, giant cell tumors, and lymphomas. It also details skeletal dysplasias such as achondroplasia, Osteogenesis Imperfecta, Ollier's disease, and metabolic bone diseases like Paget's and osteopetrosis, providing essential diagnostic and management insights for exam preparation.
Question 1
A 20-year-old male has an asymptomatic, incidentally discovered enchondroma in his proximal humerus. Radiographs show a well-defined, non-expansile lesion with typical chondroid matrix calcifications. What is the most appropriate initial management for this patient?
View Answer & Explanation
Correct Answer: C
Rationale: Enchondromas are benign lesions that are "often detected incidentally" and are typically asymptomatic. For an asymptomatic, incidentally found lesion with benign radiographic features, close observation with serial radiographs is the standard initial management to monitor for any changes. Surgical intervention is usually reserved for symptomatic lesions, pathological fractures, or suspicion of malignant transformation. Radiation, chemotherapy, and amputation are not appropriate for benign enchondromas.
Question 2
A 35-year-old female presents with mild, intermittent pain in her distal femur. Radiographs show an intramedullary lesion with some endosteal scalloping and punctate calcifications. A biopsy is performed, and the pathologist describes a hypocellular lesion with a lobular growth pattern and uniform nuclei. This histological description is consistent with which of the following?
View Answer & Explanation
Correct Answer: C
Rationale: The text and Fig. 8.23 describe enchondromas as having a "lobular growth pattern and hypocellular nature... The nuclei are uniform." This histological description is characteristic of a benign enchondroma, even if the lesion is painful or appears somewhat aggressive radiographically. The other options represent malignant tumors with different histological features.
Question 3
A 21-year-old male has an enchondroma in his proximal tibia. Histological examination of the lesion would primarily reveal cells responsible for producing which type of matrix?
View Answer & Explanation
Correct Answer: C
Rationale: The text describes enchondromas as "benign intramedullary cartilaginous lesions." Therefore, the primary cells within the lesion would be chondrocytes, which produce a cartilaginous matrix. The other options represent different tissue types not characteristic of enchondromas.
Question 4
A 7-year-old girl presents with multiple bony deformities and leg length discrepancy. Radiographs show numerous enchondromas affecting multiple bones, particularly in the lower extremities, leading to significant skeletal asymmetry. This constellation of findings is most consistent with which condition?

View Answer & Explanation
Correct Answer: C
Rationale: The clinical context for Fig. 8.22 a, b explicitly links "Short stature and osseous deformity secondary to Ollier’s disease" with multiple enchondromas. Ollier's disease is characterized by multiple enchondromas, often unilateral, leading to significant skeletal deformities and growth disturbances. The other conditions are distinct skeletal dysplasias or disorders not primarily characterized by multiple enchondromas.
Question 5
A 26-year-old male undergoes biopsy of an intramedullary lesion in his proximal femur. Histological examination reveals a cartilaginous lesion with uniform nuclei. What is the significance of "uniform nuclei" in the context of this lesion?

View Answer & Explanation
Correct Answer: C
Rationale: The text and Fig. 8.23 describe enchondromas as having "uniform nuclei," which is a histological feature of a benign lesion. Nuclear uniformity (lack of pleomorphism) is a critical indicator distinguishing benign cartilaginous lesions from malignant ones like chondrosarcoma. The other options are incorrect interpretations of this benign histological feature.
Question 6
A pathologist examines a low-power histological slide of an enchondroma from a 15-year-old patient. Which characteristic growth pattern would be most evident?

View Answer & Explanation
Correct Answer: C
Rationale: The clinical context for Fig. 8.23 a, b explicitly states, "Low-power images demonstrate the lobular growth pattern and hypocellular nature of enchondromas." This directly answers the question. The other options describe growth patterns associated with other types of bone tumors (e.g., osteosarcoma, chondrosarcoma, fibrous dysplasia).
Question 7
A 24-year-old female presents with an incidental finding of a well-defined, lucent lesion with punctate calcifications in her proximal humerus on a shoulder MRI. She denies pain or any other symptoms related to the lesion. Based on the provided information, what is the most likely benign diagnosis?
View Answer & Explanation
Correct Answer: C
Rationale: The text states that enchondromas are "often detected incidentally" and, after the short tubular bones, are commonly found in the "proximal humerus and proximal and distal femur." This makes enchondroma the most likely benign diagnosis for an incidental lesion in the proximal humerus. Osteochondromas are exophytic, non-ossifying fibromas and fibrous cortical defects are typically metaphyseal and fibrous, and simple bone cysts are fluid-filled and usually in younger patients.
Question 8
A 14-year-old boy has an enchondroma in his distal femur. Histological analysis of the lesion would primarily show cells embedded within a matrix composed of what material?
View Answer & Explanation
Correct Answer: C
Rationale: Enchondromas are defined as "intramedullary cartilaginous lesions." Cartilage is primarily composed of chondrocytes embedded in a hyaline matrix. Therefore, hyaline cartilage is the correct answer. Collagen fibers are characteristic of fibrous lesions, hydroxyapatite of bone, and adipose/hematopoietic tissues are not the primary matrix of enchondromas.
Question 9
A 29-year-old female undergoes a biopsy of an intramedullary lesion in her proximal phalanx. The low-power histological examination reveals a lobular growth pattern with widely dispersed cells within the matrix. This description points to which characteristic of enchondromas?

View Answer & Explanation
Correct Answer: C
Rationale: The clinical context for Fig. 8.23 a, b explicitly states, "Low-power images demonstrate the lobular growth pattern and hypocellular nature of enchondromas." Widely dispersed cells within the matrix is a description consistent with hypocellularity. The other options describe features not characteristic of benign enchondromas.
Question 10
A 9-year-old boy presents with progressive bowing of his right leg and a noticeable limb length discrepancy. Radiographs reveal multiple enchondromas predominantly affecting the bones of the right lower extremity, leading to significant osseous deformities. This condition is best described as:

View Answer & Explanation
Correct Answer: C
Rationale: The clinical context for Fig. 8.22 a, b explicitly states "Short stature and osseous deformity secondary to Ollier’s disease." Ollier's disease is characterized by multiple enchondromas, often unilateral, leading to significant skeletal deformities and growth disturbances. Solitary enchondroma does not involve multiple lesions. Maffucci syndrome includes hemangiomas, not mentioned. Chondrosarcoma is malignant. Fibrous dysplasia is a different bone disorder.
Question 11
A 14-year-old male presents with a 6-month history of dull, aching pain in his right thigh. Physical examination reveals mild tenderness over the mid-femur. Radiographs show an expansile, lytic lesion in the proximal diaphysis of the femur with a characteristic "ground-glass" appearance and cortical thinning. There is no periosteal reaction or soft tissue mass.
View Answer & Explanation
Correct Answer: C
Rationale: The classic "ground-glass" appearance on radiographs, along with an expansile lytic lesion in a long bone diaphysis in an adolescent, is pathognomonic for fibrous dysplasia. Enchondromas typically have a chondroid matrix and are often found in small bones of the hands/feet or metaphyses. Non-ossifying fibromas are usually cortically based and have a sclerotic rim. Aneurysmal bone cysts are typically expansile and multiloculated. Osteosarcoma would likely present with more aggressive features like periosteal reaction and a soft tissue mass.
Question 12
A 7-year-old girl presents with a history of precocious puberty, multiple café-au-lait spots with irregular borders, and recurrent fractures. Radiographs reveal polyostotic expansile lytic lesions with a ground-glass matrix affecting the femur, tibia, and pelvis. Physical examination confirms the skin lesions and signs of early puberty.
View Answer & Explanation
Correct Answer: C
Rationale: The triad of polyostotic fibrous dysplasia, café-au-lait spots (often described as "coast of Maine" due to irregular borders), and precocious puberty is characteristic of McCune-Albright Syndrome. This syndrome is caused by a somatic activating mutation in the GNAS1 gene. Neurofibromatosis Type 1 also has café-au-lait spots but typically presents with neurofibromas and Lisch nodules, and bone lesions are usually dysplastic or pseudarthrosis, not polyostotic fibrous dysplasia. Osteogenesis Imperfecta causes recurrent fractures but lacks the skin and endocrine features. Ollier's disease involves multiple enchondromas. Paget's disease is typically seen in older adults.
Question 13
A 4-year-old boy is brought to the clinic due to a history of 5 long bone fractures since birth, often from minor trauma. His parents note his sclerae have a bluish tint. Physical examination reveals normal stature, mild joint hypermobility, and no significant skeletal deformities. Radiographs show generalized osteopenia and evidence of healed fractures.
View Answer & Explanation
Correct Answer: A
Rationale: Osteogenesis Imperfecta Type I is the mildest and most common form, characterized by blue sclerae, recurrent fractures (often post-natal), normal or near-normal stature, and mild bone deformity. Type II is lethal in the perinatal period. Type III is severe, with progressive deformity, short stature, and often white or grey sclerae. Type IV is moderate, with normal sclerae and variable severity. Hypophosphatasia presents with defective bone mineralization but typically has low alkaline phosphatase and rickets-like features.
Question 14
A 6-year-old girl with a confirmed diagnosis of Osteogenesis Imperfecta Type III presents with severe progressive long bone deformities and a history of multiple fractures despite protective measures. Her parents are seeking options to reduce her fracture burden and improve bone quality.
View Answer & Explanation
Correct Answer: C
Rationale: Intravenous bisphosphonates (e.g., pamidronate, zoledronic acid) are the mainstay medical treatment for moderate to severe Osteogenesis Imperfecta. They work by inhibiting osteoclast activity, increasing bone mineral density, reducing fracture rates, and improving bone pain. While Vitamin D and calcium are important for bone health, they are not primary treatments for the underlying collagen defect in OI. Growth hormone and PTH analogs are not indicated for routine OI management.
Question 15
A 72-year-old man presents with a 9-month history of progressive right hip and lower back pain. Physical examination reveals mild bowing of the right tibia and increased skin temperature over the affected area. Laboratory tests show a significantly elevated serum alkaline phosphatase level with normal calcium and phosphate. Radiographs of the pelvis and tibia demonstrate cortical thickening, trabecular coarsening, and mixed lytic and sclerotic lesions, particularly in the ilium and proximal tibia.
View Answer & Explanation
Correct Answer: D
Rationale: The clinical presentation of bone pain, bowing deformity, elevated alkaline phosphatase, and characteristic radiographic findings (cortical thickening, trabecular coarsening, mixed lytic/sclerotic lesions) in an elderly patient is highly suggestive of Paget's Disease of Bone (osteitis deformans). Metastatic prostate cancer can cause sclerotic lesions and elevated alkaline phosphatase but typically lacks the characteristic bone remodeling pattern and bowing. Fibrous dysplasia is usually seen in younger patients. Osteomyelitis would present with signs of infection. Renal osteodystrophy has different biochemical and radiographic features.
Question 16
A 68-year-old man with a 20-year history of Paget's disease affecting his left femur and pelvis reports new onset of severe, unremitting pain in his left thigh, which is worse at night. Physical examination reveals a palpable, rapidly enlarging mass in the mid-thigh. Radiographs show an aggressive lytic lesion with cortical destruction and a soft tissue component within the previously pagetic bone.
View Answer & Explanation
Correct Answer: C
Rationale: The development of new, severe, unremitting pain and a rapidly enlarging soft tissue mass in a patient with long-standing Paget's disease, coupled with aggressive radiographic features, is highly suspicious for sarcomatous degeneration, most commonly osteosarcoma. While pathologic fractures can occur, the presence of a rapidly enlarging mass points to malignancy. Osteomyelitis would typically have signs of infection. Hypercalcemia is rare in Paget's unless immobilized. Spinal stenosis is a complication of vertebral Paget's but doesn't explain a thigh mass.
Question 17
A 3-month-old infant presents with failure to thrive, recurrent infections, hepatosplenomegaly, and progressive visual impairment. Physical examination reveals macrocephaly and frontal bossing. Radiographs show diffuse, symmetric osteosclerosis, particularly noticeable as "bone-within-a-bone" appearance in the vertebrae and long bones, and obliteration of the medullary canals.
View Answer & Explanation
Correct Answer: C
Rationale: This clinical picture describes infantile malignant osteopetrosis, a severe form of osteopetrosis. The hallmark of osteopetrosis is a defect in osteoclast function, leading to impaired bone resorption. This results in excessively dense, yet brittle, bones that obliterate marrow spaces (causing anemia and infections), compress cranial nerves (leading to visual impairment, hearing loss), and are prone to fracture. Overactive osteoclast function would lead to bone loss. Defective osteoblast function would lead to osteopenia. Abnormal collagen synthesis is seen in Osteogenesis Imperfecta. Impaired chondrocyte proliferation is seen in achondroplasia.
Question 18
A 45-year-old asymptomatic male undergoes a chest X-ray for a pre-employment physical. The radiograph incidentally reveals diffuse, symmetric increase in bone density, particularly noted in the vertebral bodies and pelvis, with a "bone-within-a-bone" appearance in the lumbar spine. His laboratory values, including calcium, phosphate, and alkaline phosphatase, are all within normal limits. He denies any history of fractures or bone pain.
View Answer & Explanation
Correct Answer: C
Rationale: The incidental finding of diffuse osteosclerosis and "bone-within-a-bone" appearance in an asymptomatic adult with normal labs is characteristic of adult benign osteopetrosis, also known as Albers-Schönberg disease. This is a milder form of osteopetrosis, often discovered incidentally. Infantile malignant osteopetrosis is severe and presents in infancy. Fluorosis can cause osteosclerosis but typically has a history of high fluoride exposure and different radiographic patterns. Myelofibrosis can cause osteosclerosis but is associated with hematologic abnormalities. DISH involves ossification of ligaments and entheses, not diffuse osteosclerosis of the entire skeleton.
Question 19
A 9-year-old boy presents with progressive bowing of his left forearm and shortening of his left leg. Physical examination reveals multiple palpable bony masses in the metaphyses of the long bones of the left upper and lower extremities. Radiographs show numerous lucent lesions with punctate calcifications, consistent with enchondromas, predominantly affecting the left side of his body. There are no associated soft tissue hemangiomas.
View Answer & Explanation
Correct Answer: C
Rationale: The presence of multiple enchondromas, often unilateral or asymmetric, leading to skeletal deformities and limb length discrepancies, without associated soft tissue hemangiomas, is characteristic of Ollier's Disease (enchondromatosis). Maffucci Syndrome is similar but includes soft tissue hemangiomas. Multiple Hereditary Exostoses involves osteochondromas (exostoses), not enchondromas. Fibrous dysplasia has a "ground-glass" appearance. Chondrosarcoma is a malignant tumor, though it can arise from enchondromas, the primary diagnosis here is the underlying syndrome.
Question 20
A 35-year-old woman with a known history of Ollier's disease presents with new onset, persistent pain in her left hip and groin. She reports that a previously stable lesion in her left ilium has recently started to grow and is now tender to palpation. Radiographs show enlargement and increased cortical irregularity of the lesion, with some areas of cortical breakthrough.
View Answer & Explanation
Correct Answer: D
Rationale: Patients with Ollier's disease have a significant risk of malignant transformation of their enchondromas into chondrosarcomas, particularly in larger, more proximal lesions (e.g., pelvis, shoulder). New onset pain, rapid growth, and aggressive radiographic features are red flags for malignant transformation. A biopsy is essential to confirm the diagnosis and guide further management. Observation is inappropriate given the suspicious changes. Chemotherapy and radiation are typically reserved for confirmed malignancy and are not initial diagnostic steps. Bisphosphonates are not indicated for enchondromas or chondrosarcomas.
Question 21
A 12-year-old boy presents with multiple palpable bony masses around his knees, shoulders, and wrists. His father and paternal grandfather also have similar bony growths. Physical examination reveals hard, immobile masses protruding from the metaphyses of the long bones, pointing away from the joint. Radiographs confirm multiple osteochondromas (exostoses) arising from the external surface of the bones near the growth plates.
View Answer & Explanation
Correct Answer: C
Rationale: This clinical presentation and family history are classic for Multiple Hereditary Exostoses (MHE), also known as diaphyseal aclasis. MHE is an autosomal dominant disorder caused by inactivating mutations in the EXT1 or EXT2 genes, which encode glycosyltransferases involved in heparan sulfate synthesis. GNAS1 mutations are associated with McCune-Albright syndrome. COL1A1/COL1A2 mutations cause Osteogenesis Imperfecta. FGFR3 mutations cause achondroplasia. TGFB1 mutations cause Camurati-Engelmann disease.
Question 22
A 40-year-old man with a lifelong history of Multiple Hereditary Exostoses (MHE) reports a new, dull ache in his left shoulder, which has been worsening over the past 3 months. He notes that a previously stable exostosis on his scapula has significantly increased in size and is now tender to touch. Physical examination confirms a firm, fixed, tender mass that appears larger than previous assessments.
View Answer & Explanation
Correct Answer: C
Rationale: The most serious complication of MHE is malignant transformation of an osteochondroma into a secondary peripheral chondrosarcoma. This risk is estimated to be 1-5% and should be suspected in adults with MHE who develop new pain or rapid growth of a previously stable exostosis, especially in large, axial lesions (e.g., pelvis, scapula). While bursitis can occur, and nerve/vascular compression are possible, the combination of new pain and rapid growth is highly concerning for malignancy and warrants urgent investigation (imaging and potentially biopsy). Pathologic fracture of an exostosis is less common and usually presents with acute pain after trauma.
Question 23
A 5-year-old boy is brought to the pediatrician due to short stature and unusual facial features. Physical examination reveals a wide, flat face, hypertelorism, and dental abnormalities including unerupted teeth. He has unusually mobile shoulders, and palpation reveals absent or hypoplastic clavicles. Radiographs confirm hypoplasia or aplasia of both clavicles, wide cranial sutures, and multiple Wormian bones.
View Answer & Explanation
Correct Answer: C
Rationale: The classic triad of absent or hypoplastic clavicles, wide cranial sutures/Wormian bones, and dental anomalies (unerupted teeth, supernumerary teeth) is pathognomonic for Cleidocranial Dysplasia. This is an autosomal dominant disorder caused by mutations in the RUNX2 gene, which is crucial for osteoblast differentiation and bone formation. Achondroplasia is characterized by rhizomelic dwarfism and normal clavicles. Osteogenesis Imperfecta causes brittle bones and blue sclerae. Marfan syndrome involves connective tissue abnormalities and tall stature. Hypophosphatasia affects bone mineralization and has low alkaline phosphatase.
Question 24
A 28-year-old woman presents with a 5-year history of progressive, dull aching pain in her right lower extremity, which is worse with activity. Physical examination reveals mild limb length discrepancy and some skin thickening over the affected limb. Radiographs of the right femur and tibia show irregular, undulating cortical hyperostosis, described as having a
Question 24
A 25-year-old male presents with a 6-month history of dull, aching pain in his right anterior tibia. Physical examination reveals mild tenderness over the mid-tibia. Radiographs show an expansile, lytic lesion with a "ground-glass" matrix and cortical thinning in the tibial diaphysis. There are no periosteal reactions or soft tissue masses.
View Answer & Explanation
Correct Answer: C
Rationale: The classic radiographic appearance of an expansile, lytic lesion with a "ground-glass" matrix in the diaphysis of a long bone in a young adult is highly characteristic of fibrous dysplasia. Enchondromas typically have a chondroid matrix (rings and arcs) and are often in the metaphysis/diaphysis. Simple bone cysts are purely lytic and often metaphyseal. Osteosarcoma would typically show more aggressive features like periosteal reaction, soft tissue mass, and osteoid matrix. Non-ossifying fibromas are usually eccentric, lobulated, and sclerotic-rimmed.
Question 24
A 7-year-old girl presents with a history of multiple pathological fractures, café-au-lait skin macules with irregular borders, and premature breast development. Radiographs reveal multiple expansile, lytic lesions with a "ground-glass" appearance affecting the femur, pelvis, and ribs.
View Answer & Explanation
Correct Answer: C
Rationale: The triad of polyostotic fibrous dysplasia, café-au-lait spots (often large and unilateral with irregular "coast of Maine" borders), and precocious puberty (due to endocrine dysfunction) is pathognomonic for McCune-Albright syndrome. Neurofibromatosis Type 1 also has café-au-lait spots, but they are typically smaller, more numerous, and have smooth "coast of California" borders, and bone lesions are usually dysplastic rather than fibrous dysplasia. Ollier's and Maffucci syndromes involve multiple enchondromas. Paget's disease is rare in children and typically affects older adults.
Question 24
A 4-year-old boy is brought to the clinic due to his third long bone fracture after a minor fall. His parents report that he has always had very fragile bones. On examination, he has normal stature, blue sclerae, and mild joint hypermobility. There is no family history of similar conditions.
View Answer & Explanation
Correct Answer: A
Rationale: Osteogenesis Imperfecta (OI) Type I is characterized by mild bone fragility, blue sclerae, normal stature, and often joint hypermobility. It is the mildest and most common form. Type II is lethal in the perinatal period. Type III is severe, progressive deforming, with very short stature and often normal sclerae. Type IV is moderate, with normal or gray sclerae and variable stature. Achondroplasia is a dwarfism characterized by rhizomelic shortening and normal bone fragility.
Question 24
A 6-year-old girl with a known diagnosis of Osteogenesis Imperfecta Type III sustains a displaced mid-diaphyseal femur fracture. She has a history of multiple previous fractures and significant bowing deformities of her lower extremities. What is the most appropriate surgical management for this fracture?
View Answer & Explanation
Correct Answer: D
Rationale: For children with severe Osteogenesis Imperfecta (especially Type III) and recurrent long bone fractures or significant deformities, telescoping intramedullary rodding (e.g., Fassier-Duval rods) is the preferred method. These rods provide internal stabilization, allow for bone growth, and can correct bowing deformities. Casting is often insufficient due to poor bone quality and high re-fracture rates. External fixation carries risks of pin tract infection and non-union. Plate fixation can lead to stress risers and re-fracture at plate ends. K-wires are typically insufficient for femoral fractures in this population.
Question 24
An 80-year-old male presents with a 9-month history of progressive left hip and lower back pain. He reports that his hat size has increased. Physical examination reveals warmth and tenderness over the left iliac crest. Laboratory tests show an elevated serum alkaline phosphatase (ALP) level, with normal calcium and phosphate. Radiographs of the pelvis show cortical thickening, trabecular coarsening, and areas of both osteolysis and osteosclerosis in the left ilium and proximal femur.
View Answer & Explanation
Correct Answer: D
Rationale: The clinical presentation of bone pain, increased hat size (indicating skull involvement), elevated alkaline phosphatase, and characteristic radiographic findings of mixed lytic and sclerotic lesions with cortical thickening and trabecular coarsening in an elderly patient is classic for Paget's disease of bone. Metastatic prostate cancer can cause sclerotic lesions and elevated ALP, but the "hat size" change and mixed lytic/sclerotic pattern are less typical. Osteomyelitis would present with acute infection signs. Fibrous dysplasia is typically seen in younger patients. Multiple myeloma causes purely lytic lesions and often hypercalcemia, not elevated ALP.
Question 24
A 72-year-old male with a 20-year history of Paget's disease affecting his right femur and pelvis presents with new onset, severe, unrelenting pain in his right thigh that is unresponsive to his usual analgesics. Physical examination reveals a palpable, firm, tender mass in the mid-thigh. Radiographs show aggressive cortical destruction and a large soft tissue mass associated with the previously pagetic femur.
View Answer & Explanation
Correct Answer: C
Rationale: The development of new, severe, unrelenting pain, a palpable mass, and aggressive radiographic changes (cortical destruction, soft tissue mass) in a bone affected by long-standing Paget's disease is highly suspicious for sarcomatous degeneration, most commonly osteosarcoma. While pathological fractures can occur, the presence of a rapidly enlarging mass and aggressive bone destruction points more towards malignancy. Osteomyelitis would typically have signs of infection. Avascular necrosis is less likely in the diaphysis. Stress fractures would not present with a soft tissue mass.
Question 24
A 3-month-old infant presents with macrocephaly, failure to thrive, and hepatosplenomegaly. Laboratory tests reveal severe anemia and thrombocytopenia. Skeletal radiographs demonstrate diffuse, marked increase in bone density throughout the skeleton, with obliteration of the medullary canals and "bone-within-a-bone" appearance in the vertebrae.
View Answer & Explanation
Correct Answer: A
Rationale: The combination of diffuse increased bone density, obliteration of medullary canals (leading to myelophthisic anemia and hepatosplenomegaly), macrocephaly (due to hydrocephalus from cranial nerve compression), and "bone-within-a-bone" appearance in an infant is characteristic of infantile malignant osteopetrosis. Rickets involves decreased bone mineralization. OI Type II is lethal and characterized by severe bone fragility, not increased density. Hypophosphatasia involves defective mineralization. Fibrous dysplasia causes lytic or ground-glass lesions, not diffuse sclerosis.
Question 24
A 45-year-old male presents with mild, intermittent headaches and occasional numbness in his right hand. He has a history of recurrent, non-displaced fractures of the tibia after minor trauma. Radiographs incidentally reveal diffuse, symmetric sclerosis of the skull base, vertebrae, and long bones, with a "sandwich vertebra" appearance. His laboratory values are normal.
View Answer & Explanation
Correct Answer: A
Rationale: This presentation of diffuse, symmetric bone sclerosis, recurrent fractures (despite increased density, the bone is brittle), and cranial nerve compression symptoms (headaches, numbness) in an adult, with characteristic "sandwich vertebra" appearance, is consistent with adult benign osteopetrosis (Albers-Schönberg disease). Paget's disease is typically asymmetric, with elevated ALP. Fluorosis causes diffuse sclerosis but is usually associated with high fluoride intake. DISH primarily affects the spine with flowing ossification of ligaments. Osteopoikilosis presents with multiple small, dense bone islands, usually asymptomatic.
Question 24
A 5-year-old boy presents with a 2-month history of localized pain and swelling over his left parietal skull. There is no history of trauma or fever. Radiographs show a well-defined lytic lesion in the parietal bone with a "beveled edge" appearance. Laboratory tests are unremarkable.
View Answer & Explanation
Correct Answer: C
Rationale: A solitary lytic lesion, particularly in the skull, with a "beveled edge" or "hole-within-a-hole" appearance in a child, is highly suggestive of eosinophilic granuloma, the mildest form of Langerhans Cell Histiocytosis. Osteomyelitis would typically present with fever, elevated inflammatory markers, and less well-defined margins. Ewing sarcoma is aggressive with periosteal reaction and soft tissue mass. Osteosarcoma is rare in the skull and has a more aggressive, blastic appearance. Fibrous dysplasia in the skull can be expansile but less commonly has the "beveled edge" appearance.
Question 24
A 9-year-old girl presents with progressive bowing of her left forearm and shortening of her left leg. Physical examination reveals multiple firm, non-tender masses palpable along the metaphyses of the long bones in her left upper and lower extremities. Radiographs show multiple radiolucent lesions with punctate calcifications, consistent with enchondromas, predominantly affecting one side of her body.
View Answer & Explanation
Correct Answer: C
Rationale: The presence of multiple enchondromas, often unilateral or asymmetric, leading to limb length discrepancies and deformities, is characteristic of Ollier's disease (enchondromatosis). Maffucci syndrome is Ollier's disease combined with soft tissue hemangiomas. Multiple hereditary exostoses involve osteochondromas, not enchondromas. Fibrous dysplasia has a different radiographic appearance (ground-glass). Osteochondromatosis is a less specific term, often referring to MHE.
Question 24
A 12-year-old boy presents with multiple firm, non-tender masses in his hands and feet, which have been slowly growing. He also has several bluish, compressible lesions on his skin and subcutaneous tissues of the affected limbs. Radiographs show multiple enchondromas in the phalanges and metacarpals, along with phleboliths in the soft tissue lesions.
View Answer & Explanation
Correct Answer: C
Rationale: Maffucci syndrome is characterized by the combination of multiple enchondromas (similar to Ollier's disease) and soft tissue hemangiomas or lymphangiomas. The bluish, compressible lesions and phleboliths are indicative of hemangiomas. Ollier's disease lacks the vascular lesions. Klippel-Trenaunay and Sturge-Weber syndromes are primarily vascular malformation syndromes with different skeletal involvement. Neurofibromatosis Type 1 has café-au-lait spots and neurofibromas, not enchondromas and hemangiomas.
Question 24
A 6-year-old boy is brought to the clinic because his parents noticed multiple hard, bony bumps around his knees and shoulders. His father has similar bumps. Physical examination reveals multiple palpable, hard masses near the metaphyses of the distal femurs, proximal tibias, and proximal humeri. Radiographs show multiple pedunculated and sessile bony outgrowths arising from the external surface of the bones, pointing away from the adjacent joint.
View Answer & Explanation
Correct Answer: B
Rationale: The presence of multiple bony outgrowths (osteochondromas) near the growth plates, often with a family history, is characteristic of Multiple Hereditary Exostoses (MHE). A solitary osteochondroma would not involve multiple lesions. Fibrous dysplasia and enchondroma are intraosseous lesions with different radiographic appearances. Osteomas are typically benign bone tumors of the skull or facial bones, not long bones.
Question 24
A 10-year-old boy presents with progressive muscle weakness, fatigue, and a waddling gait. His parents note that his limbs appear unusually thick. Physical examination reveals symmetric muscle atrophy and tenderness over the long bones. Radiographs show diffuse, symmetric cortical thickening and medullary canal narrowing of the diaphyses of the femurs, tibias, and humeri, with a "bone-within-a-bone" appearance in some areas.
View Answer & Explanation
Correct Answer: C
Rationale: Progressive diaphyseal dysplasia, also known as Camurati-Engelmann disease, is characterized by symmetric cortical thickening and medullary canal narrowing of the diaphyses of long bones, leading to bone pain, muscle weakness, and a waddling gait. Paget's disease is typically asymmetric and affects older adults. Osteopetrosis involves diffuse sclerosis of the entire bone, not just the diaphysis, and often presents with hematologic issues. Fibrous dysplasia causes lytic or ground-glass lesions. Osteoid osteoma is a small, painful lesion with a central nidus.
Question 24
A 35-year-old female presents with chronic, progressive pain and stiffness in her right lower extremity, which has worsened over several years. Physical examination reveals a thickened, indurated skin over the affected limb. Radiographs show irregular, undulating cortical hyperostosis along the diaphysis of the right femur and tibia, resembling "flowing candle wax" or "dripping candle wax" on one side of the bone.
View Answer & Explanation
Correct Answer: B
Rationale: The characteristic radiographic appearance of "flowing candle wax" or "dripping candle wax" hyperostosis along the cortex of a long bone, often associated with pain and skin changes, is pathognomonic for melorheostosis. Osteopoikilosis presents with multiple small, dense bone islands. Osteopathia striata shows linear striations of increased density. Fibrous dysplasia has a ground-glass appearance. Paget's disease has a mixed lytic/sclerotic pattern with cortical thickening but not the "flowing" appearance.
Question 24
An 18-year-old male with monostotic fibrous dysplasia of the proximal femur presents with increasing pain and a limp. Radiographs show an expansile lesion with significant cortical thinning and a shepherd's crook deformity. He is at high risk for a pathological fracture.
View Answer & Explanation
Correct Answer: D
Rationale: For symptomatic fibrous dysplasia of the proximal femur with impending fracture or significant deformity (like shepherd's crook), surgical stabilization is indicated. Intramedullary nailing provides stable fixation, especially for the femur, and can help correct deformity. Curettage and bone grafting (autograft or allograft) or cement augmentation are often performed to fill the defect and provide structural support. Observation is inappropriate for impending fracture. Radiation therapy is contraindicated due to the risk of malignant transformation. Bisphosphonates can reduce pain and fracture risk but are usually adjunctive, not primary treatment for impending fracture. Wide en bloc excision is rarely performed due to the benign nature and extensive involvement, especially in the proximal femur.
Question 24
A 5-year-old girl is diagnosed with Osteogenesis Imperfecta Type I. Her parents ask about the underlying cause of her condition. Which of the following is the primary genetic defect responsible for most cases of Osteogenesis Imperfecta?
View Answer & Explanation
Correct Answer: C
Rationale: Osteogenesis Imperfecta (OI) is primarily caused by mutations in the COL1A1 or COL1A2 genes, which encode the alpha-1 and alpha-2 chains of Type I collagen, respectively. These mutations lead to either reduced production of normal collagen (Type I) or production of abnormal collagen (Types II, III, IV). FGFR3 mutations cause achondroplasia. GNAS1 mutations are associated with McCune-Albright syndrome. RANKL is involved in osteoclast differentiation. SOX9 is involved in chondrogenesis.
Question 24
A 68-year-old male with symptomatic Paget's disease of the lumbar spine and pelvis, confirmed by radiographs and elevated alkaline phosphatase, is seeking medical management for his bone pain. What is the first-line pharmacologic treatment for symptomatic Paget's disease?
View Answer & Explanation
Correct Answer: C
Rationale: Bisphosphonates are the first-line pharmacologic treatment for symptomatic Paget's disease of bone. They inhibit osteoclast activity, reducing bone turnover and pain, and improving bone quality. Calcitonin is less potent and rarely used now. Corticosteroids are not indicated. NSAIDs can help with pain but do not address the underlying bone pathology. Parathyroid hormone analogs are used for osteoporosis, not Paget's disease.
Question 24
Osteopetrosis is a group of rare genetic disorders characterized by increased bone density and fragility. What is the primary cellular defect underlying the pathophysiology of osteopetrosis?
Question 25
A 25-year-old male presents with a 6-month history of dull, aching pain in his right anterior tibia. Physical examination reveals mild tenderness over the mid-tibia. Radiographs show an expansile, lytic lesion with a "ground-glass" matrix and cortical thinning in the tibial diaphysis. There are no periosteal reactions or soft tissue masses.
View Answer & Explanation
Correct Answer: C
Rationale: The classic radiographic appearance of an expansile, lytic lesion with a "ground-glass" matrix in the diaphysis of a long bone in a young adult is highly characteristic of fibrous dysplasia. Enchondromas typically have a chondroid matrix (rings and arcs) and are often in the metaphysis/diaphysis. Simple bone cysts are purely lytic and often metaphyseal. Osteosarcoma would typically show more aggressive features like periosteal reaction, soft tissue mass, and osteoid matrix. Non-ossifying fibromas are usually eccentric, lobulated, and sclerotic-rimmed.
Question 26
A 7-year-old girl presents with a history of multiple pathological fractures, café-au-lait skin macules with irregular borders, and premature breast development. Radiographs reveal multiple expansile, lytic lesions with a "ground-glass" appearance affecting the femur, pelvis, and ribs.
View Answer & Explanation
Correct Answer: C
Rationale: The triad of polyostotic fibrous dysplasia, café-au-lait spots (often large and unilateral with irregular "coast of Maine" borders), and precocious puberty (due to endocrine dysfunction) is pathognomonic for McCune-Albright syndrome. Neurofibromatosis Type 1 also has café-au-lait spots, but they are typically smaller, more numerous, and have smooth "coast of California" borders, and bone lesions are usually dysplastic rather than fibrous dysplasia. Ollier's and Maffucci syndromes involve multiple enchondromas. Paget's disease is rare in children and typically affects older adults.
Question 27
A 4-year-old boy is brought to the clinic due to his third long bone fracture after a minor fall. His parents report that he has always had very fragile bones. On examination, he has normal stature, blue sclerae, and mild joint hypermobility. There is no family history of similar conditions.
View Answer & Explanation
Correct Answer: A
Rationale: Osteogenesis Imperfecta (OI) Type I is characterized by mild bone fragility, blue sclerae, normal stature, and often joint hypermobility. It is the mildest and most common form. Type II is lethal in the perinatal period. Type III is severe, progressive deforming, with very short stature and often normal sclerae. Type IV is moderate, with normal or gray sclerae and variable stature. Achondroplasia is a dwarfism characterized by rhizomelic shortening and normal bone fragility.
Question 28
A 6-year-old girl with a known diagnosis of Osteogenesis Imperfecta Type III sustains a displaced mid-diaphyseal femur fracture. She has a history of multiple previous fractures and significant bowing deformities of her lower extremities. What is the most appropriate surgical management for this fracture?
View Answer & Explanation
Correct Answer: D
Rationale: For children with severe Osteogenesis Imperfecta (especially Type III) and recurrent long bone fractures or significant deformities, telescoping intramedullary rodding (e.g., Fassier-Duval rods) is the preferred method. These rods provide internal stabilization, allow for bone growth, and can correct bowing deformities. Casting is often insufficient due to poor bone quality and high re-fracture rates. External fixation carries risks of pin tract infection and non-union. Plate fixation can lead to stress risers and re-fracture at plate ends. K-wires are typically insufficient for femoral fractures in this population.
Question 29
An 80-year-old male presents with a 9-month history of progressive left hip and lower back pain. He reports that his hat size has increased. Physical examination reveals warmth and tenderness over the left iliac crest. Laboratory tests show an elevated serum alkaline phosphatase (ALP) level, with normal calcium and phosphate. Radiographs of the pelvis show cortical thickening, trabecular coarsening, and areas of both osteolysis and osteosclerosis in the left ilium and proximal femur.
View Answer & Explanation
Correct Answer: D
Rationale: The clinical presentation of bone pain, increased hat size (indicating skull involvement), elevated alkaline phosphatase, and characteristic radiographic findings of mixed lytic and sclerotic lesions with cortical thickening and trabecular coarsening in an elderly patient is classic for Paget's disease of bone. Metastatic prostate cancer can cause sclerotic lesions and elevated ALP, but the "hat size" change and mixed lytic/sclerotic pattern are less typical. Osteomyelitis would present with acute infection signs. Fibrous dysplasia is typically seen in younger patients. Multiple myeloma causes purely lytic lesions and often hypercalcemia, not elevated ALP.
Question 30
A 72-year-old male with a 20-year history of Paget's disease affecting his right femur and pelvis presents with new onset, severe, unrelenting pain in his right thigh that is unresponsive to his usual analgesics. Physical examination reveals a palpable, firm, tender mass in the mid-thigh. Radiographs show aggressive cortical destruction and a large soft tissue mass associated with the previously pagetic femur.
View Answer & Explanation
Correct Answer: C
Rationale: The development of new, severe, unrelenting pain, a palpable mass, and aggressive radiographic changes (cortical destruction, soft tissue mass) in a bone affected by long-standing Paget's disease is highly suspicious for sarcomatous degeneration, most commonly osteosarcoma. While pathological fractures can occur, the presence of a rapidly enlarging mass and aggressive bone destruction points more towards malignancy. Osteomyelitis would typically have signs of infection. Avascular necrosis is less likely in the diaphysis. Stress fractures would not present with a soft tissue mass.
Question 31
A 3-month-old infant presents with macrocephaly, failure to thrive, and hepatosplenomegaly. Laboratory tests reveal severe anemia and thrombocytopenia. Skeletal radiographs demonstrate diffuse, marked increase in bone density throughout the skeleton, with obliteration of the medullary canals and "bone-within-a-bone" appearance in the vertebrae.
View Answer & Explanation
Correct Answer: A
Rationale: The combination of diffuse increased bone density, obliteration of medullary canals (leading to myelophthisic anemia and hepatosplenomegaly), macrocephaly (due to hydrocephalus from cranial nerve compression), and "bone-within-a-bone" appearance in an infant is characteristic of infantile malignant osteopetrosis. Rickets involves decreased bone mineralization. OI Type II is lethal and characterized by severe bone fragility, not increased density. Hypophosphatasia involves defective mineralization. Fibrous dysplasia causes lytic or ground-glass lesions, not diffuse sclerosis.
Question 32
A 45-year-old male presents with mild, intermittent headaches and occasional numbness in his right hand. He has a history of recurrent, non-displaced fractures of the tibia after minor trauma. Radiographs incidentally reveal diffuse, symmetric sclerosis of the skull base, vertebrae, and long bones, with a "sandwich vertebra" appearance. His laboratory values are normal.
View Answer & Explanation
Correct Answer: A
Rationale: This presentation of diffuse, symmetric bone sclerosis, recurrent fractures (despite increased density, the bone is brittle), and cranial nerve compression symptoms (headaches, numbness) in an adult, with characteristic "sandwich vertebra" appearance, is consistent with adult benign osteopetrosis (Albers-Schönberg disease). Paget's disease is typically asymmetric, with elevated ALP. Fluorosis causes diffuse sclerosis but is usually associated with high fluoride intake. DISH primarily affects the spine with flowing ossification of ligaments. Osteopoikilosis presents with multiple small, dense bone islands, usually asymptomatic.
Question 33
A 5-year-old boy presents with a 2-month history of localized pain and swelling over his left parietal skull. There is no history of trauma or fever. Radiographs show a well-defined lytic lesion in the parietal bone with a "beveled edge" appearance. Laboratory tests are unremarkable.
View Answer & Explanation
Correct Answer: C
Rationale: A solitary lytic lesion, particularly in the skull, with a "beveled edge" or "hole-within-a-hole" appearance in a child, is highly suggestive of eosinophilic granuloma, the mildest form of Langerhans Cell Histiocytosis. Osteomyelitis would typically present with fever, elevated inflammatory markers, and less well-defined margins. Ewing sarcoma is aggressive with periosteal reaction and soft tissue mass. Osteosarcoma is rare in the skull and has a more aggressive, blastic appearance. Fibrous dysplasia in the skull can be expansile but less commonly has the "beveled edge" appearance.
Question 34
A 9-year-old girl presents with progressive bowing of her left forearm and shortening of her left leg. Physical examination reveals multiple firm, non-tender masses palpable along the metaphyses of the long bones in her left upper and lower extremities. Radiographs show multiple radiolucent lesions with punctate calcifications, consistent with enchondromas, predominantly affecting one side of her body.
View Answer & Explanation
Correct Answer: C
Rationale: The presence of multiple enchondromas, often unilateral or asymmetric, leading to limb length discrepancies and deformities, is characteristic of Ollier's disease (enchondromatosis). Maffucci syndrome is Ollier's disease combined with soft tissue hemangiomas. Multiple hereditary exostoses involve osteochondromas, not enchondromas. Fibrous dysplasia has a different radiographic appearance (ground-glass). Osteochondromatosis is a less specific term, often referring to MHE.
Question 35
A 12-year-old boy presents with multiple firm, non-tender masses in his hands and feet, which have been slowly growing. He also has several bluish, compressible lesions on his skin and subcutaneous tissues of the affected limbs. Radiographs show multiple enchondromas in the phalanges and metacarpals, along with phleboliths in the soft tissue lesions.
View Answer & Explanation
Correct Answer: C
Rationale: Maffucci syndrome is characterized by the combination of multiple enchondromas (similar to Ollier's disease) and soft tissue hemangiomas or lymphangiomas. The bluish, compressible lesions and phleboliths are indicative of hemangiomas. Ollier's disease lacks the vascular lesions. Klippel-Trenaunay and Sturge-Weber syndromes are primarily vascular malformation syndromes with different skeletal involvement. Neurofibromatosis Type 1 has café-au-lait spots and neurofibromas, not enchondromas and hemangiomas.
Question 36
A 6-year-old boy is brought to the clinic because his parents noticed multiple hard, bony bumps around his knees and shoulders. His father has similar bumps. Physical examination reveals multiple palpable, hard masses near the metaphyses of the distal femurs, proximal tibias, and proximal humeri. Radiographs show multiple pedunculated and sessile bony outgrowths arising from the external surface of the bones, pointing away from the adjacent joint.
View Answer & Explanation
Correct Answer: B
Rationale: The presence of multiple bony outgrowths (osteochondromas) near the growth plates, often with a family history, is characteristic of Multiple Hereditary Exostoses (MHE). A solitary osteochondroma would not involve multiple lesions. Fibrous dysplasia and enchondroma are intraosseous lesions with different radiographic appearances. Osteomas are typically benign bone tumors of the skull or facial bones, not long bones.
Question 37
A 10-year-old boy presents with progressive muscle weakness, fatigue, and a waddling gait. His parents note that his limbs appear unusually thick. Physical examination reveals symmetric muscle atrophy and tenderness over the long bones. Radiographs show diffuse, symmetric cortical thickening and medullary canal narrowing of the diaphyses of the femurs, tibias, and humeri, with a "bone-within-a-bone" appearance in some areas.
View Answer & Explanation
Correct Answer: C
Rationale: Progressive diaphyseal dysplasia, also known as Camurati-Engelmann disease, is characterized by symmetric cortical thickening and medullary canal narrowing of the diaphyses of long bones, leading to bone pain, muscle weakness, and a waddling gait. Paget's disease is typically asymmetric and affects older adults. Osteopetrosis involves diffuse sclerosis of the entire bone, not just the diaphysis, and often presents with hematologic issues. Fibrous dysplasia causes lytic or ground-glass lesions. Osteoid osteoma is a small, painful lesion with a central nidus.
Question 38
A 35-year-old female presents with chronic, progressive pain and stiffness in her right lower extremity, which has worsened over several years. Physical examination reveals a thickened, indurated skin over the affected limb. Radiographs show irregular, undulating cortical hyperostosis along the diaphysis of the right femur and tibia, resembling "flowing candle wax" or "dripping candle wax" on one side of the bone.
View Answer & Explanation
Correct Answer: B
Rationale: The characteristic radiographic appearance of "flowing candle wax" or "dripping candle wax" hyperostosis along the cortex of a long bone, often associated with pain and skin changes, is pathognomonic for melorheostosis. Osteopoikilosis presents with multiple small, dense bone islands. Osteopathia striata shows linear striations of increased density. Fibrous dysplasia has a ground-glass appearance. Paget's disease has a mixed lytic/sclerotic pattern with cortical thickening but not the "flowing" appearance.
Question 39
An 18-year-old male with monostotic fibrous dysplasia of the proximal femur presents with increasing pain and a limp. Radiographs show an expansile lesion with significant cortical thinning and a shepherd's crook deformity. He is at high risk for a pathological fracture.
View Answer & Explanation
Correct Answer: D
Rationale: For symptomatic fibrous dysplasia of the proximal femur with impending fracture or significant deformity (like shepherd's crook), surgical stabilization is indicated. Intramedullary nailing provides stable fixation, especially for the femur, and can help correct deformity. Curettage and bone grafting (autograft or allograft) or cement augmentation are often performed to fill the defect and provide structural support. Observation is inappropriate for impending fracture. Radiation therapy is contraindicated due to the risk of malignant transformation. Bisphosphonates can reduce pain and fracture risk but are usually adjunctive, not primary treatment for impending fracture. Wide en bloc excision is rarely performed due to the benign nature and extensive involvement, especially in the proximal femur.
Question 40
A 5-year-old girl is diagnosed with Osteogenesis Imperfecta Type I. Her parents ask about the underlying cause of her condition. Which of the following is the primary genetic defect responsible for most cases of Osteogenesis Imperfecta?
View Answer & Explanation
Correct Answer: C
Rationale: Osteogenesis Imperfecta (OI) is primarily caused by mutations in the COL1A1 or COL1A2 genes, which encode the alpha-1 and alpha-2 chains of Type I collagen, respectively. These mutations lead to either reduced production of normal collagen (Type I) or production of abnormal collagen (Types II, III, IV). FGFR3 mutations cause achondroplasia. GNAS1 mutations are associated with McCune-Albright syndrome. RANKL is involved in osteoclast differentiation. SOX9 is involved in chondrogenesis.
Question 41
A 68-year-old male with symptomatic Paget's disease of the lumbar spine and pelvis, confirmed by radiographs and elevated alkaline phosphatase, is seeking medical management for his bone pain. What is the first-line pharmacologic treatment for symptomatic Paget's disease?
View Answer & Explanation
Correct Answer: C
Rationale: Bisphosphonates are the first-line pharmacologic treatment for symptomatic Paget's disease of bone. They inhibit osteoclast activity, reducing bone turnover and pain, and improving bone quality. Calcitonin is less potent and rarely used now. Corticosteroids are not indicated. NSAIDs can help with pain but do not address the underlying bone pathology. Parathyroid hormone analogs are used for osteoporosis, not Paget's disease.
Question 42
A 3-month-old infant presents with generalized hypotonia and delayed head control. Physical examination reveals disproportionately short limbs, a large head, and a prominent forehead. The parents are of normal stature. Genetic testing is pending.
View Answer & Explanation
Correct Answer: C
Rationale: Achondroplasia is inherited in an autosomal dominant manner, but over 80% of cases are due to a "de novo" mutation of a gene localized to the distal short arm of chromosome 4, especially when parents have normal stature. Autosomal recessive inheritance (A) is incorrect as achondroplasia is autosomal dominant. X-linked dominant (B), mitochondrial (D), and germline mosaicism (E) are not the primary genetic mechanisms for the vast majority of achondroplasia cases.
Question 43
A genetic counselor is discussing the epidemiology of skeletal dysplasias with a couple who have a family history of short stature. They specifically inquire about the prevalence of achondroplasia.
View Answer & Explanation
Correct Answer: C
Rationale: Achondroplasia occurs in three of 100,000 live births, making it the most common human chondrodysplasia. Options A, B, D, and E represent incorrect incidence rates for achondroplasia.
Question 44
A 5-year-old child presents with short stature. Physical examination reveals significantly shortened limbs, but the trunk length appears relatively normal for age. The head is disproportionately large.
View Answer & Explanation
Correct Answer: B
Rationale: Achondroplasia is defined as a disproportionate short-limb dwarfism, characterized by short limbs and a relatively normal trunk height. Proportionate dwarfism (A) would involve all body parts being proportionally small. Short-trunk dwarfism (C) would involve a shortened trunk with relatively normal limbs. Primordial (D) and pituitary (E) dwarfism are typically proportionate.
Question 45
A 6-month-old infant diagnosed with achondroplasia is brought for a follow-up visit. The parents express concern about their child's development, noting that the infant seems "floppy" and is not meeting typical milestones.
View Answer & Explanation
Correct Answer: C
Rationale: In infancy, hypotonia is typical in achondroplasia, and acquisition of developmental motor milestones is often delayed. Early acquisition of walking (A) and normal muscle tone (B) are incorrect. Cognitive development (D) is usually normal, not advanced. Hypotonia is typically present (E).
Question 46
A 3-month-old infant with achondroplasia presents to the emergency department with episodes of apnea, stridor, and difficulty feeding. The parents report increasing lethargy.
View Answer & Explanation
Correct Answer: C
Rationale: Compression of the spinal cord (especially at the craniocervical junction) and upper airway obstruction are known to increase the risk of death in infancy for individuals with achondroplasia. The symptoms described (apnea, stridor, lethargy) are highly suggestive of these life-threatening complications. Renal failure (A), cardiac anomalies (B), gastrointestinal malformations (D), and immunodeficiency (E) are not specifically highlighted as primary causes of increased infant mortality in achondroplasia in the provided text.
Question 47
A 25-year-old male with achondroplasia is seeking advice regarding potential limb lengthening procedures. He asks about the typical adult height for individuals with his condition.
View Answer & Explanation
Correct Answer: C
Rationale: The mean adult height in males with achondroplasia is 131 ± 5.6 cm. Options A, B, D, and E are outside this typical range.
Question 48
A 2-year-old child is suspected of having achondroplasia. On physical examination, the physician notes specific craniofacial characteristics.

View Answer & Explanation
Correct Answer: C
Rationale: As described and depicted in Fig. 1.11, the head is disproportionately large in relation to height, the forehead is prominent, and the nasal bridge is broadened and depressed in achondroplasia. Options A, B, D, and E describe features not characteristic of achondroplasia.
Question 49
A 10-year-old boy with achondroplasia is being compared to a peer of similar age without the condition. The physician observes differences in their body proportions, particularly regarding the trunk and chest.

View Answer & Explanation
Correct Answer: B
Rationale: Fig. 1.10 and its caption state that "There is no difference between them in the height of the trunk; however, the chest and shoulders are narrower in achondroplasia." This directly supports option B. Options A, C, D, and E describe features that contradict the provided information.
Question 50
A 7-year-old girl with achondroplasia presents with increasing lower back pain and a waddling gait. On examination, the physician observes a pronounced spinal curvature in the lumbar region.

View Answer & Explanation
Correct Answer: C
Rationale: Fig. 1.12 and the text explicitly state that "Exaggerated lumbar lordosis" is common in achondroplasia. While other spinal issues can occur, exaggerated lumbar lordosis is a characteristic finding. Severe thoracic kyphosis (A) and scoliosis (B) are not the primary characteristic spinal curvature mentioned. Cervical instability (D) is a risk but not the specific lumbar curvature. Flattening of the lumbar spine (E) is the opposite of what is observed.
Question 51
During a physical examination of a 4-year-old child with achondroplasia, the orthopedic surgeon assesses the range of motion of the upper extremities, specifically focusing on the elbow joints.

View Answer & Explanation
Correct Answer: C
Rationale: The text and Fig. 1.12 caption state that "limitation of elbow extension and rotation" is common in achondroplasia. Hyperextension (A) is incorrect for the elbow, though it can occur in other joints. Full extension (B) is incorrect. Elbow valgus (D) and flexion contracture without rotational limitation (E) are not the specific characteristic findings mentioned.
Question 52
A 6-year-old boy with achondroplasia is noted to have an abnormal gait. On examination of his lower extremities, specific knee deformities are observed.

View Answer & Explanation
Correct Answer: B
Rationale: The text and Fig. 1.12 caption state that "genu varum, hyperextension of the knees" is common in achondroplasia. Genu valgum (A) is the opposite of genu varum. Normal alignment (C) is incorrect. Patellar instability (D) and fixed flexion deformity (E) are not the primary characteristic knee findings mentioned.
Question 53
A 12-year-old patient with achondroplasia undergoes a general musculoskeletal examination. The physician tests for joint stability and range of motion in various joints, including the ankles, wrists, and fingers.
View Answer & Explanation
Correct Answer: C
Rationale: The text states that "hyperextension of the knees and most other joints is common" in achondroplasia. Generalized joint stiffness (A) or limited range of motion in all major joints (B) are incorrect. While some joints might have limitations (e.g., elbow), generalized hyperextension is a key feature. Recurrent joint dislocations (D) are not specifically mentioned as a common finding. Normal joint laxity (E) is incorrect.
Question 54
A 3-year-old child with achondroplasia is being evaluated. The parents are concerned about the appearance of their child's hands and fingers, comparing them to other children with short stature.

View Answer & Explanation
Correct Answer: B
Rationale: Fig. 1.13 and its caption state that "The fingers in achondroplasia are not as
Question 54
A 6-year-old male with a known diagnosis of achondroplasia presents for a routine orthopedic check-up. On physical examination, specific joint limitations are noted.
View Answer & Explanation
Correct Answer: B
Rationale: The clinical case specifically states that "limitation of elbow extension and rotation" is a common finding in achondroplasia (Fig. 1.12). This is a characteristic feature of the condition due to abnormal bone growth. Increased range of motion at the elbow (A) is incorrect as limitation is expected.
Question 54
A 3-month-old infant diagnosed with achondroplasia exhibits hypotonia and delayed motor milestones. Parents are counseled on potential life-threatening complications in infancy.
View Answer & Explanation
Correct Answer: B
Rationale: The clinical text highlights that "Compression of the spinal cord and upper airway obstruction increase the risk of death in infancy" in individuals with achondroplasia. Renal failure (A) is not a primary life-threatening complication associated with achondroplasia in infancy.
Question 54
A 30-year-old male with achondroplasia is being evaluated. Compared to individuals of normal stature, what is a characteristic finding regarding his trunk and chest morphology?
View Answer & Explanation
Correct Answer: B
Rationale: Fig. 1.10 and its accompanying text state: "There is no difference between them in the height of the trunk; however, the chest and shoulders are narrower in achondroplasia." This indicates a normal trunk height but a narrower chest and shoulders. Shorter trunk height (A) is incorrect as trunk height is typically normal.
Question 54
A 4-year-old female with achondroplasia is examined. Her parents inquire about the appearance of her hands. What is a characteristic feature of the fingers in achondroplasia?
View Answer & Explanation
Correct Answer: B
Rationale: Fig. 1.13 and its context state: "The fingers in achondroplasia are not as short as in many other short-limb dwarfism." This distinguishes achondroplasia from other forms of dwarfism where finger shortening might be more pronounced. Markedly shortened and stubby fingers (A) is a common misconception but is not specifically stated as the characteristic feature compared to other conditions.
Question 54
A newborn is diagnosed with achondroplasia. Genetic testing confirms a de novo mutation. This gene is localized to which specific chromosomal region?
View Answer & Explanation
Correct Answer: B
Rationale: The clinical text states that achondroplasia results from a "de novo" mutation of a gene, localized to the distal short arm of chromosome 4. This is a key genetic identifier for the condition. Other chromosomal locations (A, C, D, E) are incorrect.
Question 54
The parents of a 1-year-old child recently diagnosed with achondroplasia express concerns about their child's cognitive development and long-term prognosis. What information should be provided regarding intelligence and life span?
View Answer & Explanation
Correct Answer: C
Rationale: The clinical text explicitly states: "Intelligence and life span are usually normal." This is an important reassuring point for parents. Options suggesting intellectual disability or reduced life span (A, B, D) are incorrect, although there is an increased risk of death in infancy due to specific complications.
Question 54
A 5-year-old male with achondroplasia undergoes a lumbar spine radiograph due to persistent back pain. What characteristic radiographic finding is expected regarding the interpediculate distance in the lumbar spine?
View Answer & Explanation
Correct Answer: C
Rationale: Fig. 1.14 and its description state: "The interpediculate distance decreases from upper to lower lumbar spine (a)." This is a classic radiographic sign of achondroplasia, contributing to spinal canal narrowing. The normal pattern is for the interpediculate distance to increase or remain relatively constant, making a decrease (A) a key diagnostic feature.
Question 54
A lateral lumbar spine radiograph of a 7-year-old female with achondroplasia is reviewed. What characteristic finding is expected regarding the pedicles?
View Answer & Explanation
Correct Answer: C
Rationale: Fig. 1.14 and its description state: "Characteristic short pedicles are seen on the lateral view (b)." Short pedicles contribute to the overall narrowing of the spinal canal, which is a significant clinical concern in achondroplasia. Elongated pedicles (A) is the opposite of the expected finding.
Question 54
A genetic counselor is educating a couple about the epidemiology of achondroplasia. What is the approximate incidence of achondroplasia in live births?
View Answer & Explanation
Correct Answer: C
Rationale: The clinical text states that achondroplasia "occurs in three of 100,000 live births." This makes it the most common human chondrodysplasia. Other incidence rates (A, B, D, E) are incorrect.
Question 54
A 2-year-old child presents with disproportionate short stature. On physical examination, the head appears large in relation to height, the forehead is prominent, and the nasal bridge is broadened and depressed. These findings are characteristic of which condition?
View Answer & Explanation
Correct Answer: C
Rationale: Fig. 1.11 and its description clearly state: "The head is disproportionately large in relation to height, the forehead is prominent, and nasal bridge is broadened and depressed." These are classic craniofacial features of achondroplasia. Spondyloepiphyseal dysplasia (A) presents with different skeletal and facial features, and Marfan syndrome (D) is characterized by tall stature and arachnodactyly.
Question 54
A medical student is preparing for a presentation on skeletal dysplasias. Achondroplasia is best classified as which type of dwarfism?
View Answer & Explanation
Correct Answer: C
Rationale: The clinical text defines achondroplasia as "a disproportionate short-limb dwarfism." This classification highlights that the limbs are disproportionately shorter than the trunk. Proportionate dwarfism (A) implies all body parts are scaled down equally, which is not the case in achondroplasia.
Question 54
Among the various human chondrodysplasias, which condition is recognized as by far the most common?
View Answer & Explanation
Correct Answer: D
Rationale: The clinical text states: "Achondroplasia is a disproportionate short-limb dwarfism, by far the most common of the human chondrodysplasias." This is a fundamental fact about the prevalence of the condition. Other options (A, B, C, E) are less common chondrodysplasias.
Question 54
A couple with normal stature has a child diagnosed with achondroplasia. They are concerned about the genetic implications. What percentage of achondroplasia cases are typically the result of a de novo mutation in individuals with parents of normal stature?
View Answer & Explanation
Correct Answer: D
Rationale: The clinical text specifies: "Over 80% of individuals with achondroplasia have parents with normal stature and have achondroplasia as the result of a 'de novo' mutation." This high percentage of spontaneous mutations is a crucial genetic aspect of the disease. Approximately 25% (B) is incorrect and might be confused with the risk for offspring of affected individuals.
Question 54
A 7-year-old male with achondroplasia presents with progressive bowing of his legs. On examination, he exhibits a common lower limb deformity.
View Answer & Explanation
Correct Answer: C
Rationale: Fig. 1.12 and its accompanying text list "genu varum" (bowlegs) as a common finding in achondroplasia. This is a characteristic lower limb deformity. Genu valgum (A), or knock-knees, is less common or may develop later after surgical correction of varus.
Question 54
A 10-year-old female with achondroplasia is noted to have a prominent anterior pelvic tilt and a characteristic spinal curvature. What is a common finding in the spine of individuals with achondroplasia?
View Answer & Explanation
Correct Answer: C
Rationale: Fig. 1.12 and its description state: "Exaggerated lumbar lordosis... is common." This is a hallmark spinal deformity in achondroplasia, often contributing to back pain and spinal stenosis. Thoracic kyphosis (A) can occur but is not described as the primary characteristic spinal curvature in the provided text.
Question 54
The parents of a 9-month-old infant with achondroplasia are concerned that their child is not yet crawling. What is typically observed regarding motor development in infants with achondroplasia?
Question 55
A 6-year-old male with a known diagnosis of achondroplasia presents for a routine orthopedic check-up. On physical examination, specific joint limitations are noted.

View Answer & Explanation
Correct Answer: B
Rationale: The clinical case specifically states that "limitation of elbow extension and rotation" is a common finding in achondroplasia (Fig. 1.12). This is a characteristic feature of the condition due to abnormal bone growth. Increased range of motion at the elbow (A) is incorrect as limitation is expected.
Question 56
A 3-month-old infant diagnosed with achondroplasia exhibits hypotonia and delayed motor milestones. Parents are counseled on potential life-threatening complications in infancy.
View Answer & Explanation
Correct Answer: B
Rationale: The clinical text highlights that "Compression of the spinal cord and upper airway obstruction increase the risk of death in infancy" in individuals with achondroplasia. Renal failure (A) is not a primary life-threatening complication associated with achondroplasia in infancy.
Question 57
A 30-year-old male with achondroplasia is being evaluated. Compared to individuals of normal stature, what is a characteristic finding regarding his trunk and chest morphology?

View Answer & Explanation
Correct Answer: B
Rationale: Fig. 1.10 and its accompanying text state: "There is no difference between them in the height of the trunk; however, the chest and shoulders are narrower in achondroplasia." This indicates a normal trunk height but a narrower chest and shoulders. Shorter trunk height (A) is incorrect as trunk height is typically normal.
Question 58
A 4-year-old female with achondroplasia is examined. Her parents inquire about the appearance of her hands. What is a characteristic feature of the fingers in achondroplasia?

View Answer & Explanation
Correct Answer: B
Rationale: Fig. 1.13 and its context state: "The fingers in achondroplasia are not as short as in many other short-limb dwarfism." This distinguishes achondroplasia from other forms of dwarfism where finger shortening might be more pronounced. Markedly shortened and stubby fingers (A) is a common misconception but is not specifically stated as the characteristic feature compared to other conditions.
Question 59
A newborn is diagnosed with achondroplasia. Genetic testing confirms a de novo mutation. This gene is localized to which specific chromosomal region?
View Answer & Explanation
Correct Answer: B
Rationale: The clinical text states that achondroplasia results from a "de novo" mutation of a gene, localized to the distal short arm of chromosome 4. This is a key genetic identifier for the condition. Other chromosomal locations (A, C, D, E) are incorrect.
Question 60
The parents of a 1-year-old child recently diagnosed with achondroplasia express concerns about their child's cognitive development and long-term prognosis. What information should be provided regarding intelligence and life span?
View Answer & Explanation
Correct Answer: C
Rationale: The clinical text explicitly states: "Intelligence and life span are usually normal." This is an important reassuring point for parents. Options suggesting intellectual disability or reduced life span (A, B, D) are incorrect, although there is an increased risk of death in infancy due to specific complications.
Question 61
A 5-year-old male with achondroplasia undergoes a lumbar spine radiograph due to persistent back pain. What characteristic radiographic finding is expected regarding the interpediculate distance in the lumbar spine?

View Answer & Explanation
Correct Answer: C
Rationale: Fig. 1.14 and its description state: "The interpediculate distance decreases from upper to lower lumbar spine (a)." This is a classic radiographic sign of achondroplasia, contributing to spinal canal narrowing. The normal pattern is for the interpediculate distance to increase or remain relatively constant, making a decrease (A) a key diagnostic feature.
Question 62
A lateral lumbar spine radiograph of a 7-year-old female with achondroplasia is reviewed. What characteristic finding is expected regarding the pedicles?

View Answer & Explanation
Correct Answer: C
Rationale: Fig. 1.14 and its description state: "Characteristic short pedicles are seen on the lateral view (b)." Short pedicles contribute to the overall narrowing of the spinal canal, which is a significant clinical concern in achondroplasia. Elongated pedicles (A) is the opposite of the expected finding.
Question 63
A genetic counselor is educating a couple about the epidemiology of achondroplasia. What is the approximate incidence of achondroplasia in live births?
View Answer & Explanation
Correct Answer: C
Rationale: The clinical text states that achondroplasia "occurs in three of 100,000 live births." This makes it the most common human chondrodysplasia. Other incidence rates (A, B, D, E) are incorrect.
Question 64
A 2-year-old child presents with disproportionate short stature. On physical examination, the head appears large in relation to height, the forehead is prominent, and the nasal bridge is broadened and depressed. These findings are characteristic of which condition?

View Answer & Explanation
Correct Answer: C
Rationale: Fig. 1.11 and its description clearly state: "The head is disproportionately large in relation to height, the forehead is prominent, and nasal bridge is broadened and depressed." These are classic craniofacial features of achondroplasia. Spondyloepiphyseal dysplasia (A) presents with different skeletal and facial features, and Marfan syndrome (D) is characterized by tall stature and arachnodactyly.
Question 65
A medical student is preparing for a presentation on skeletal dysplasias. Achondroplasia is best classified as which type of dwarfism?
View Answer & Explanation
Correct Answer: C
Rationale: The clinical text defines achondroplasia as "a disproportionate short-limb dwarfism." This classification highlights that the limbs are disproportionately shorter than the trunk. Proportionate dwarfism (A) implies all body parts are scaled down equally, which is not the case in achondroplasia.
Question 66
Among the various human chondrodysplasias, which condition is recognized as by far the most common?
View Answer & Explanation
Correct Answer: D
Rationale: The clinical text states: "Achondroplasia is a disproportionate short-limb dwarfism, by far the most common of the human chondrodysplasias." This is a fundamental fact about the prevalence of the condition. Other options (A, B, C, E) are less common chondrodysplasias.
Question 67
A couple with normal stature has a child diagnosed with achondroplasia. They are concerned about the genetic implications. What percentage of achondroplasia cases are typically the result of a de novo mutation in individuals with parents of normal stature?
View Answer & Explanation
Correct Answer: D
Rationale: The clinical text specifies: "Over 80% of individuals with achondroplasia have parents with normal stature and have achondroplasia as the result of a 'de novo' mutation." This high percentage of spontaneous mutations is a crucial genetic aspect of the disease. Approximately 25% (B) is incorrect and might be confused with the risk for offspring of affected individuals.
Question 68
A 7-year-old male with achondroplasia presents with progressive bowing of his legs. On examination, he exhibits a common lower limb deformity.

View Answer & Explanation
Correct Answer: C
Rationale: Fig. 1.12 and its accompanying text list "genu varum" (bowlegs) as a common finding in achondroplasia. This is a characteristic lower limb deformity. Genu valgum (A), or knock-knees, is less common or may develop later after surgical correction of varus.
Question 69
A 10-year-old female with achondroplasia is noted to have a prominent anterior pelvic tilt and a characteristic spinal curvature. What is a common finding in the spine of individuals with achondroplasia?

View Answer & Explanation
Correct Answer: C
Rationale: Fig. 1.12 and its description state: "Exaggerated lumbar lordosis... is common." This is a hallmark spinal deformity in achondroplasia, often contributing to back pain and spinal stenosis. Thoracic kyphosis (A) can occur but is not described as the primary characteristic spinal curvature in the provided text.
Question 70
A 30-year-old male presents with pain and swelling in his distal femur. Radiographs show an expansile lytic lesion involving the epiphysis, extending to the subchondral bone, with no evidence of matrix mineralization or sclerotic rim.
View Answer & Explanation
Correct Answer: A
Rationale: Giant cell tumor (GCT) is a benign aggressive tumor typically found in the epiphysis of young adults (20-40 years old), consistent with the patient's age and lesion location. The radiographic features of a lytic, expansile epiphyseal lesion without matrix mineralization or a sclerotic rim are classic for GCT. Main Distractor: Osteosarcoma typically affects the metaphysis and often shows osteoid matrix mineralization, which is not described here.
Question 71
A 35-year-old female presents with knee pain. Plain radiographs of the proximal tibia are shown.

View Answer & Explanation
Correct Answer: A
Rationale: As noted in the clinical context for Fig. 8.52, giant cell tumors characteristically occur in the epiphysis or apophysis of long bones, as seen in the provided image. This is a key diagnostic feature. Main Distractor: The absence of a sclerotic rim is characteristic of GCT, not its presence. A sclerotic rim is often seen in other benign lesions like non-ossifying fibromas.
Question 72
A 28-year-old male presents to the emergency department with acute, severe pain and inability to bear weight on his distal femur after a minor fall. Radiographs reveal a lytic epiphyseal lesion with a cortical breach.
View Answer & Explanation
Correct Answer: B
Rationale: The clinical context states that approximately 5% of patients with giant cell tumor of bone present with a pathologic fracture. Main Distractor: 15% is within the range for the risk of malignant transformation, not the incidence of pathologic fracture.
Question 73
A 32-year-old female with a suspected giant cell tumor of the distal radius undergoes MRI.
View Answer & Explanation
Correct Answer: C
Rationale: The clinical context states that giant cell tumors have low to intermediate signal on T1-weighted MRI sequences. Main Distractor: High signal on T1 is typically seen in fatty lesions, hemorrhage, or proteinaceous fluid, which is not characteristic of GCT.
Question 74
A 25-year-old male presents with ankle pain. MRI reveals an epiphyseal lesion in the distal tibia.
View Answer & Explanation
Correct Answer: C
Rationale: The clinical context states that giant cell tumors have high signal on STIR or T2-weighted MRI sequences due to their cellularity and fluid content. Main Distractor: Low signal on T2 is more characteristic of fibrous lesions, heavily calcified lesions, or cortical bone.
Question 75
A 32-year-old female undergoes intralesional curettage for a proximal tibia epiphyseal lesion. The surgeon describes the resected tissue.

View Answer & Explanation
Correct Answer: C
Rationale: As described in the clinical context for Fig. 8.55, grossly, giant cell tumors are composed of friable, brownish-red material. Main Distractor: White, cartilaginous material would be characteristic of a chondroid tumor, such as an enchondroma or chondrosarcoma.
Question 76
A biopsy is performed on an epiphyseal lesion in a 29-year-old male. Microscopic examination is shown.

View Answer & Explanation
Question 76
A 35-year-old male presents with chronic knee pain. Radiographs show an epiphyseal lytic lesion in the proximal tibia without matrix mineralization or surrounding sclerosis. An MRI is ordered for further characterization. Which of the following signal characteristics would be most consistent with a giant cell tumor?
View Answer & Explanation
Correct Answer: C
Rationale: According to the text, giant cell tumors have low to intermediate signal on T1 or proton density sequences, high signal on STIR or T2 sequences, and enhance with administration of gadolinium. Option A describes characteristics more typical of a fibrous lesion or scar. Option B and D describe incorrect T1 signal characteristics. Option E describes incorrect T2 signal characteristics.
Question 76
A 28-year-old female undergoes intralesional curettage for a giant cell tumor of the distal femur. During the procedure, the surgeon notes the gross appearance of the lesion. Which of the following best describes the typical gross appearance of a giant cell tumor?
View Answer & Explanation
Correct Answer: C
Rationale: The text states, "Grossly, lesions are composed of friable, brownish–red material." This is a direct description from the provided clinical context. The other options describe appearances typical of other benign or malignant bone lesions (e.g., enchondroma, lipoma, chondrosarcoma, fibrous dysplasia) but not giant cell tumor.
Question 76
A 32-year-old male presents with a painful lesion in his proximal humerus. Biopsy confirms a giant cell tumor. On microscopic examination, which of the following features is characteristic of a giant cell tumor?
View Answer & Explanation
Correct Answer: C
Rationale: The text explicitly states, "Microscopically, lesions have giant cells interspersed against a background of mononuclear cells with round or oval nuclei. The cells composing the giant cells should be similar in appearance to the background cells. Mitotic fi gures may be present." Option A describes fibrous lesions, Option B describes cartilaginous lesions, Option D describes metastatic carcinoma, and Option E describes fatty lesions or bone marrow.
Question 76
A 38-year-old female presents with progressive back pain and radicular symptoms. Imaging reveals a lytic lesion in a vertebral body. Given her age and symptoms, a giant cell tumor is suspected. In the spine, giant cell tumors typically occur in which anatomical location?
View Answer & Explanation
Correct Answer: C
Rationale: The text states, "Spine lesions usually occur in the anterior column and may present with radicular or compressive symptoms." The anterior column primarily refers to the vertebral body. The other options describe less common or incorrect locations for GCT in the spine.
Question 76
A 30-year-old male is diagnosed with a giant cell tumor of the thoracic spine. Based on the typical presentation of spinal giant cell tumors, which of the following symptoms is he most likely to experience?
View Answer & Explanation
Correct Answer: B
Rationale: The text specifies that "Spine lesions usually occur in the anterior column and may present with radicular or compressive symptoms." The other options are not described as typical presentations for spinal GCTs in the provided text.
Question 76
A 25-year-old female with a known giant cell tumor of the distal radius presents to the emergency department after a fall, complaining of acute wrist pain and deformity. Radiographs confirm a fracture through the lesion. What percentage of patients with giant cell tumors typically experience a pathologic fracture?
View Answer & Explanation
Correct Answer: B
Rationale: The text states that clinical presentation occasionally includes "pathologic fracture," specifying "5%." The other percentages are incorrect based on the provided information.
Question 76
A 33-year-old male is being evaluated for a giant cell tumor of the proximal tibia. As part of the workup, a chest CT scan is often performed to screen for potential distant disease. What approximate percentage of patients with giant cell tumors develop lung metastases?
View Answer & Explanation
Correct Answer: B
Rationale: The text indicates, "Approximately 2% of the patients develop lung metastases." The other percentages are not supported by the provided text.
Question 76
A 29-year-old female with a history of a resected giant cell tumor of the distal femur is found to have multiple small pulmonary nodules on a routine follow-up chest CT scan. Given the typical behavior of giant cell tumor lung metastases, what is the most likely prognosis for these lesions?
View Answer & Explanation
Correct Answer: B
Rationale: The text explicitly states that lung metastases "usually run a benign course." While they require monitoring, they are not typically indicative of aggressive or widespread malignancy as described in the other options.
Question 76
A 40-year-old male presents with a recurrent giant cell tumor in the distal tibia, which was previously treated with intralesional curettage and adjuvant radiation therapy. Biopsy of the recurrent lesion shows features concerning for malignant transformation. Which factor is most commonly associated with malignancy in giant cell tumors?
View Answer & Explanation
Correct Answer: C
Rationale: The text states, "Malignancy in giant cell tumor occurs in 5–15%, at the site of a previous giant cell tumor (usually associated with radiation) or rarely de novo associated with benign giant cell tumor." Previous radiation is specifically highlighted as a common association. The other options are not identified as primary risk factors for malignant transformation in the provided text.
Question 76
A 37-year-old female with a long-standing history of a giant cell tumor in her proximal humerus develops new pain and rapid growth of the lesion. A biopsy reveals malignant transformation. What is the reported incidence range for malignancy occurring in giant cell tumors?
View Answer & Explanation
Correct Answer: C
Rationale: The text states, "Malignancy in giant cell tumor occurs in 5–15%." The other ranges are incorrect based on the provided information.
Question 76
A 30-year-old male presents with pain and swelling around his knee. Radiographs reveal a lytic lesion in the proximal tibia. Given the patient's age and the radiographic findings, a giant cell tumor is high on the differential. What is the typical age range for patients diagnosed with giant cell tumors?
View Answer & Explanation
Correct Answer: C
Rationale: The text states, "Giant cell tumors usually occur in patients between the age of 20 and 40." This corresponds to young adults. The other age ranges are not typical for GCT.
Question 76
A 27-year-old female presents with pain in her wrist. Radiographs show a lytic lesion in the distal radius. Given the suspected diagnosis of a giant cell tumor, which specific anatomical region of the bone is most characteristic for its occurrence?
View Answer & Explanation
Correct Answer: C
Rationale: The text states, "Giant cell tumor is a benign aggressive bone lesion that occurs in the epiphysis or apophysis (secondary ossifi cation center)." This is a hallmark characteristic of GCT. The other locations are typical for other bone tumors (e.g., osteosarcoma in metaphysis, Ewing's sarcoma in diaphysis).
Question 76
A 34-year-old male presents with knee pain. Plain radiographs, as shown, reveal a lytic lesion in the proximal tibia. Which radiographic feature, specifically related to matrix mineralization, is characteristic of a giant cell tumor?
View Answer & Explanation
Correct Answer: C
Rationale: The caption for Fig. 8.52 a, b explicitly states, "Note the epiphyseal location, absence of matrix mineralization, and lack of sclerosis surrounding the lesion." The presence of matrix mineralization would suggest other bone tumors like chondrosarcoma or osteosarcoma.
Question 76
A 26-year-old female presents with ankle pain. Radiographs show a lytic lesion in the distal tibia, consistent with a giant cell tumor. Which radiographic feature, concerning the lesion's border, is characteristic of a giant cell tumor?
View Answer & Explanation
Correct Answer: C
Rationale: The caption for Fig. 8.52 a, b explicitly states, "Note the epiphyseal location, absence of matrix mineralization, and lack of sclerosis surrounding the lesion." The presence of a sclerotic rim would suggest a more benign or less aggressive lesion, while periosteal reactions like Codman's triangle or sunburst are associated with aggressive malignant tumors like osteosarcoma.
Question 76
A 31-year-old male is diagnosed with a giant cell tumor of the proximal femur. Based on its biological behavior, how is a giant cell tumor best characterized?
View Answer & Explanation
Correct Answer: B
Rationale: The very first sentence of the text states, "Giant cell tumor is a benign aggressive bone lesion." This accurately describes its nature, distinguishing it from purely benign lesions (A) or overtly malignant tumors (C, D). It is also a neoplastic process, not merely reactive (E).
Question 76
A 22-year-old female presents with a giant cell tumor located near her knee joint. Which of the following clinical symptoms is commonly associated with giant cell tumors due to their proximity to joints?
View Answer & Explanation
Correct Answer: C
Rationale: The text lists "limitation of joint motion" as one of the clinical presentations of giant cell tumors. This is consistent with their epiphyseal location near joints. The other options are not described as typical symptoms of GCT.
Question 76
A 39-year-old male presents with chronic pain and weakness in his arm, diagnosed with a giant cell tumor of the distal humerus. Which muscle-related clinical finding is commonly associated with giant cell tumors?
View Answer & Explanation
Correct Answer: C
Rationale: The text lists "regional muscle atrophy" as one of the clinical presentations of giant cell tumors. This can occur due to disuse or chronic pain associated with the lesion. The other options are not typical presentations of GCT.
Question 76
A pathologist is reviewing a biopsy specimen from a 28-year-old patient with a suspected giant cell tumor. On microscopic examination, numerous giant cells are observed. What is a crucial distinguishing feature of the giant cells in a giant cell tumor compared to the background mononuclear cells?
View Answer & Explanation
Correct Answer: B
Rationale: The text states, "The cells composing the giant cells should be similar in appearance to the background cells." This similarity is a key diagnostic feature differentiating GCT from other giant cell-rich lesions where the giant cells might be reactive and morphologically distinct from the neoplastic stromal cells. Option A describes a feature that would argue against GCT. The other options describe features not specified as distinguishing characteristics in the provided text.
Question 76
A 36-year-old male undergoes an MRI for a suspected giant cell tumor of the distal femur. The MRI includes sequences with and without contrast. Which of the following enhancement patterns is expected for a giant cell tumor?
View Answer & Explanation
Correct Answer: C
Rationale: The text states that giant cell tumors "enhance with administration of gadolinium." While the specific pattern isn't detailed as "diffuse," it implies significant enhancement throughout the lesion, consistent with its vascularity and cellularity. The other options describe absent, limited, or specific patterns not generally characteristic of GCT enhancement as per the text.
Question 76
A 29-year-old female presents with knee pain. Plain radiographs, as shown, reveal a lytic lesion. Based on the image and the typical characteristics of a giant cell tumor, which bone and specific location is depicted?
View Answer & Explanation
Correct Answer: B
Rationale: The caption for Fig. 8.52 a, b explicitly states, "Plain radiographs... showing giant cell tumor of the proximal tibia. Note the epiphyseal location..." This directly identifies the bone and location. The other options are incorrect based on the provided image and its description.
Question 76
A 35-year-old male presents with chronic knee pain. Radiographs show an epiphyseal lytic lesion in the proximal tibia without matrix mineralization or surrounding sclerosis. An MRI is ordered for further characterization. Which of the following signal characteristics would be most consistent with a giant cell tumor?
View Answer & Explanation
Correct Answer: C
Rationale: According to the text, giant cell tumors have low to intermediate signal on T1 or proton density sequences, high signal on STIR or T2 sequences, and enhance with administration of gadolinium. Option A describes characteristics more typical of a fibrous lesion or scar. Option B and D describe incorrect T1 signal characteristics. Option E describes incorrect T2 signal characteristics.
Question 76
A 28-year-old female undergoes intralesional curettage for a giant cell tumor of the distal femur. During the procedure, the surgeon notes the gross appearance of the lesion. Which of the following best describes the typical gross appearance of a giant cell tumor?
View Answer & Explanation
Correct Answer: C
Rationale: The text states, "Grossly, lesions are composed of friable, brownish–red material." This is a direct description from the provided clinical context. The other options describe appearances typical of other benign or malignant bone lesions (e.g., enchondroma, lipoma, chondrosarcoma, fibrous dysplasia) but not giant cell tumor.
Question 76
A 32-year-old male presents with a painful lesion in his proximal humerus. Biopsy confirms a giant cell tumor. On microscopic examination, which of the following features is characteristic of a giant cell tumor?
View Answer & Explanation
Correct Answer: C
Rationale: The text explicitly states, "Microscopically, lesions have giant cells interspersed against a background of mononuclear cells with round or oval nuclei. The cells composing the giant cells should be similar in appearance to the background cells. Mitotic fi gures may be present." Option A describes fibrous lesions, Option B describes cartilaginous lesions, Option D describes metastatic carcinoma, and Option E describes fatty lesions or bone marrow.
Question 76
A 38-year-old female presents with progressive back pain and radicular symptoms. Imaging reveals a lytic lesion in a vertebral body. Given her age and symptoms, a giant cell tumor is suspected. In the spine, giant cell tumors typically occur in which anatomical location?
View Answer & Explanation
Correct Answer: C
Rationale: The text states, "Spine lesions usually occur in the anterior column and may present with radicular or compressive symptoms." The anterior column primarily refers to the vertebral body. The other options describe less common or incorrect locations for GCT in the spine.
Question 76
A 30-year-old male is diagnosed with a giant cell tumor of the thoracic spine. Based on the typical presentation of spinal giant cell tumors, which of the following symptoms is he most likely to experience?
View Answer & Explanation
Correct Answer: B
Rationale: The text specifies that "Spine lesions usually occur in the anterior column and may present with radicular or compressive symptoms." The other options are not described as typical presentations for spinal GCTs in the provided text.
Question 76
A 25-year-old female with a known giant cell tumor of the distal radius presents to the emergency department after a fall, complaining of acute wrist pain and deformity. Radiographs confirm a fracture through the lesion. What percentage of patients with giant cell tumors typically experience a pathologic fracture?
View Answer & Explanation
Correct Answer: B
Rationale: The text states that clinical presentation occasionally includes "pathologic fracture," specifying "5%." The other percentages are incorrect based on the provided information.
Question 76
A 33-year-old male is being evaluated for a giant cell tumor of the proximal tibia. As part of the workup, a chest CT scan is often performed to screen for potential distant disease. What approximate percentage of patients with giant cell tumors develop lung metastases?
View Answer & Explanation
Correct Answer: B
Rationale: The text indicates, "Approximately 2% of the patients develop lung metastases." The other percentages are not supported by the provided text.
Question 76
A 29-year-old female with a history of a resected giant cell tumor of the distal femur is found to have multiple small pulmonary nodules on a routine follow-up chest CT scan. Given the typical behavior of giant cell tumor lung metastases, what is the most likely prognosis for these lesions?
View Answer & Explanation
Correct Answer: B
Rationale: The text explicitly states that lung metastases "usually run a benign course." While they require monitoring, they are not typically indicative of aggressive or widespread malignancy as described in the other options.
Question 76
A 40-year-old male presents with a recurrent giant cell tumor in the distal tibia, which was previously treated with intralesional curettage and adjuvant radiation therapy. Biopsy of the recurrent lesion shows features concerning for malignant transformation. Which factor is most commonly associated with malignancy in giant cell tumors?
View Answer & Explanation
Correct Answer: C
Rationale: The text states, "Malignancy in giant cell tumor occurs in 5–15%, at the site of a previous giant cell tumor (usually associated with radiation) or rarely de novo associated with benign giant cell tumor." Previous radiation is specifically highlighted as a common association. The other options are not identified as primary risk factors for malignant transformation in the provided text.
Question 76
A 37-year-old female with a long-standing history of a giant cell tumor in her proximal humerus develops new pain and rapid growth of the lesion. A biopsy reveals malignant transformation. What is the reported incidence range for malignancy occurring in giant cell tumors?
View Answer & Explanation
Correct Answer: C
Rationale: The text states, "Malignancy in giant cell tumor occurs in 5–15%." The other ranges are incorrect based on the provided information.
Question 76
A 30-year-old male presents with pain and swelling around his knee. Radiographs reveal a lytic lesion in the proximal tibia. Given the patient's age and the radiographic findings, a giant cell tumor is high on the differential. What is the typical age range for patients diagnosed with giant cell tumors?
View Answer & Explanation
Correct Answer: C
Rationale: The text states, "Giant cell tumors usually occur in patients between the age of 20 and 40." This corresponds to young adults. The other age ranges are not typical for GCT.
Question 76
A 27-year-old female presents with pain in her wrist. Radiographs show a lytic lesion in the distal radius. Given the suspected diagnosis of a giant cell tumor, which specific anatomical region of the bone is most characteristic for its occurrence?
View Answer & Explanation
Correct Answer: C
Rationale: The text states, "Giant cell tumor is a benign aggressive bone lesion that occurs in the epiphysis or apophysis (secondary ossifi cation center)." This is a hallmark characteristic of GCT. The other locations are typical for other bone tumors (e.g., osteosarcoma in metaphysis, Ewing's sarcoma in diaphysis).
Question 76
A 34-year-old male presents with knee pain. Plain radiographs, as shown, reveal a lytic lesion in the proximal tibia. Which radiographic feature, specifically related to matrix mineralization, is characteristic of a giant cell tumor?
View Answer & Explanation
Correct Answer: C
Rationale: The caption for Fig. 8.52 a, b explicitly states, "Note the epiphyseal location, absence of matrix mineralization, and lack of sclerosis surrounding the lesion." The presence of matrix mineralization would suggest other bone tumors like chondrosarcoma or osteosarcoma.
Question 76
A 26-year-old female presents with ankle pain. Radiographs show a lytic lesion in the distal tibia, consistent with a giant cell tumor. Which radiographic feature, concerning the lesion's border, is characteristic of a giant cell tumor?
View Answer & Explanation
Correct Answer: C
Rationale: The caption for Fig. 8.52 a, b explicitly states, "Note the epiphyseal location, absence of matrix mineralization, and lack of sclerosis surrounding the lesion." The presence of a sclerotic rim would suggest a more benign or less aggressive lesion, while periosteal reactions like Codman's triangle or sunburst are associated with aggressive malignant tumors like osteosarcoma.
Question 76
A 31-year-old male is diagnosed with a giant cell tumor of the proximal femur. Based on its biological behavior, how is a giant cell tumor best characterized?
View Answer & Explanation
Correct Answer: B
Rationale: The very first sentence of the text states, "Giant cell tumor is a benign aggressive bone lesion." This accurately describes its nature, distinguishing it from purely benign lesions (A) or overtly malignant tumors (C, D). It is also a neoplastic process, not merely reactive (E).
Question 76
A 22-year-old female presents with a giant cell tumor located near her knee joint. Which of the following clinical symptoms is commonly associated with giant cell tumors due to their proximity to joints?
View Answer & Explanation
Correct Answer: C
Rationale: The text lists "limitation of joint motion" as one of the clinical presentations of giant cell tumors. This is consistent with their epiphyseal location near joints. The other options are not described as typical symptoms of GCT.
Question 76
A 39-year-old male presents with chronic pain and weakness in his arm, diagnosed with a giant cell tumor of the distal humerus. Which muscle-related clinical finding is commonly associated with giant cell tumors?
View Answer & Explanation
Correct Answer: C
Rationale: The text lists "regional muscle atrophy" as one of the clinical presentations of giant cell tumors. This can occur due to disuse or chronic pain associated with the lesion. The other options are not typical presentations of GCT.
Question 76
A pathologist is reviewing a biopsy specimen from a 28-year-old patient with a suspected giant cell tumor. On microscopic examination, numerous giant cells are observed. What is a crucial distinguishing feature of the giant cells in a giant cell tumor compared to the background mononuclear cells?
View Answer & Explanation
Correct Answer: B
Rationale: The text states, "The cells composing the giant cells should be similar in appearance to the background cells." This similarity is a key diagnostic feature differentiating GCT from other giant cell-rich lesions where the giant cells might be reactive and morphologically distinct from the neoplastic stromal cells. Option A describes a feature that would argue against GCT. The other options describe features not specified as distinguishing characteristics in the provided text.
Question 76
A 36-year-old male undergoes an MRI for a suspected giant cell tumor of the distal femur. The MRI includes sequences with and without contrast. Which of the following enhancement patterns is expected for a giant cell tumor?
View Answer & Explanation
Correct Answer: C
Rationale: The text states that giant cell tumors "enhance with administration of gadolinium." While the specific pattern isn't detailed as "diffuse," it implies significant enhancement throughout the lesion, consistent with its vascularity and cellularity. The other options describe absent, limited, or specific patterns not generally characteristic of GCT enhancement as per the text.
Question 76
A 29-year-old female presents with knee pain. Plain radiographs, as shown, reveal a lytic lesion. Based on the image and the typical characteristics of a giant cell tumor, which bone and specific location is depicted?
View Answer & Explanation
Correct Answer: B
Rationale: The caption for Fig. 8.52 a, b explicitly states, "Plain radiographs... showing giant cell tumor of the proximal tibia. Note the epiphyseal location..." This directly identifies the bone and location. The other options are incorrect based on the provided image and its description.
Question 77
A 35-year-old male presents with chronic knee pain. Radiographs show an epiphyseal lytic lesion in the proximal tibia without matrix mineralization or surrounding sclerosis. An MRI is ordered for further characterization. Which of the following signal characteristics would be most consistent with a giant cell tumor?

View Answer & Explanation
Correct Answer: C
Rationale: According to the text, giant cell tumors have low to intermediate signal on T1 or proton density sequences, high signal on STIR or T2 sequences, and enhance with administration of gadolinium. Option A describes characteristics more typical of a fibrous lesion or scar. Option B and D describe incorrect T1 signal characteristics. Option E describes incorrect T2 signal characteristics.
Question 78
A 28-year-old female undergoes intralesional curettage for a giant cell tumor of the distal femur. During the procedure, the surgeon notes the gross appearance of the lesion. Which of the following best describes the typical gross appearance of a giant cell tumor?

View Answer & Explanation
Correct Answer: C
Rationale: The text states, "Grossly, lesions are composed of friable, brownish–red material." This is a direct description from the provided clinical context. The other options describe appearances typical of other benign or malignant bone lesions (e.g., enchondroma, lipoma, chondrosarcoma, fibrous dysplasia) but not giant cell tumor.
Question 79
A 32-year-old male presents with a painful lesion in his proximal humerus. Biopsy confirms a giant cell tumor. On microscopic examination, which of the following features is characteristic of a giant cell tumor?

View Answer & Explanation
Correct Answer: C
Rationale: The text explicitly states, "Microscopically, lesions have giant cells interspersed against a background of mononuclear cells with round or oval nuclei. The cells composing the giant cells should be similar in appearance to the background cells. Mitotic fi gures may be present." Option A describes fibrous lesions, Option B describes cartilaginous lesions, Option D describes metastatic carcinoma, and Option E describes fatty lesions or bone marrow.
Question 80
A 38-year-old female presents with progressive back pain and radicular symptoms. Imaging reveals a lytic lesion in a vertebral body. Given her age and symptoms, a giant cell tumor is suspected. In the spine, giant cell tumors typically occur in which anatomical location?
View Answer & Explanation
Correct Answer: C
Rationale: The text states, "Spine lesions usually occur in the anterior column and may present with radicular or compressive symptoms." The anterior column primarily refers to the vertebral body. The other options describe less common or incorrect locations for GCT in the spine.
Question 81
A 30-year-old male is diagnosed with a giant cell tumor of the thoracic spine. Based on the typical presentation of spinal giant cell tumors, which of the following symptoms is he most likely to experience?
View Answer & Explanation
Correct Answer: B
Rationale: The text specifies that "Spine lesions usually occur in the anterior column and may present with radicular or compressive symptoms." The other options are not described as typical presentations for spinal GCTs in the provided text.
Question 82
A 25-year-old female with a known giant cell tumor of the distal radius presents to the emergency department after a fall, complaining of acute wrist pain and deformity. Radiographs confirm a fracture through the lesion. What percentage of patients with giant cell tumors typically experience a pathologic fracture?
View Answer & Explanation
Correct Answer: B
Rationale: The text states that clinical presentation occasionally includes "pathologic fracture," specifying "5%." The other percentages are incorrect based on the provided information.
Question 83
A 33-year-old male is being evaluated for a giant cell tumor of the proximal tibia. As part of the workup, a chest CT scan is often performed to screen for potential distant disease. What approximate percentage of patients with giant cell tumors develop lung metastases?
View Answer & Explanation
Correct Answer: B
Rationale: The text indicates, "Approximately 2% of the patients develop lung metastases." The other percentages are not supported by the provided text.
Question 84
A 29-year-old female with a history of a resected giant cell tumor of the distal femur is found to have multiple small pulmonary nodules on a routine follow-up chest CT scan. Given the typical behavior of giant cell tumor lung metastases, what is the most likely prognosis for these lesions?
View Answer & Explanation
Correct Answer: B
Rationale: The text explicitly states that lung metastases "usually run a benign course." While they require monitoring, they are not typically indicative of aggressive or widespread malignancy as described in the other options.
Question 85
A 40-year-old male presents with a recurrent giant cell tumor in the distal tibia, which was previously treated with intralesional curettage and adjuvant radiation therapy. Biopsy of the recurrent lesion shows features concerning for malignant transformation. Which factor is most commonly associated with malignancy in giant cell tumors?
View Answer & Explanation
Correct Answer: C
Rationale: The text states, "Malignancy in giant cell tumor occurs in 5–15%, at the site of a previous giant cell tumor (usually associated with radiation) or rarely de novo associated with benign giant cell tumor." Previous radiation is specifically highlighted as a common association. The other options are not identified as primary risk factors for malignant transformation in the provided text.
Question 86
A 37-year-old female with a long-standing history of a giant cell tumor in her proximal humerus develops new pain and rapid growth of the lesion. A biopsy reveals malignant transformation. What is the reported incidence range for malignancy occurring in giant cell tumors?
View Answer & Explanation
Correct Answer: C
Rationale: The text states, "Malignancy in giant cell tumor occurs in 5–15%." The other ranges are incorrect based on the provided information.
Question 87
A 30-year-old male presents with pain and swelling around his knee. Radiographs reveal a lytic lesion in the proximal tibia. Given the patient's age and the radiographic findings, a giant cell tumor is high on the differential. What is the typical age range for patients diagnosed with giant cell tumors?
View Answer & Explanation
Correct Answer: C
Rationale: The text states, "Giant cell tumors usually occur in patients between the age of 20 and 40." This corresponds to young adults. The other age ranges are not typical for GCT.
Question 88
A 27-year-old female presents with pain in her wrist. Radiographs show a lytic lesion in the distal radius. Given the suspected diagnosis of a giant cell tumor, which specific anatomical region of the bone is most characteristic for its occurrence?
View Answer & Explanation
Correct Answer: C
Rationale: The text states, "Giant cell tumor is a benign aggressive bone lesion that occurs in the epiphysis or apophysis (secondary ossifi cation center)." This is a hallmark characteristic of GCT. The other locations are typical for other bone tumors (e.g., osteosarcoma in metaphysis, Ewing's sarcoma in diaphysis).
Question 89
A 34-year-old male presents with knee pain. Plain radiographs, as shown, reveal a lytic lesion in the proximal tibia. Which radiographic feature, specifically related to matrix mineralization, is characteristic of a giant cell tumor?

View Answer & Explanation
Correct Answer: C
Rationale: The caption for Fig. 8.52 a, b explicitly states, "Note the epiphyseal location, absence of matrix mineralization, and lack of sclerosis surrounding the lesion." The presence of matrix mineralization would suggest other bone tumors like chondrosarcoma or osteosarcoma.
Question 90
A 26-year-old female presents with ankle pain. Radiographs show a lytic lesion in the distal tibia, consistent with a giant cell tumor. Which radiographic feature, concerning the lesion's border, is characteristic of a giant cell tumor?

View Answer & Explanation
Correct Answer: C
Rationale: The caption for Fig. 8.52 a, b explicitly states, "Note the epiphyseal location, absence of matrix mineralization, and lack of sclerosis surrounding the lesion." The presence of a sclerotic rim would suggest a more benign or less aggressive lesion, while periosteal reactions like Codman's triangle or sunburst are associated with aggressive malignant tumors like osteosarcoma.
Question 91
A 31-year-old male is diagnosed with a giant cell tumor of the proximal femur. Based on its biological behavior, how is a giant cell tumor best characterized?
View Answer & Explanation
Correct Answer: B
Rationale: The very first sentence of the text states, "Giant cell tumor is a benign aggressive bone lesion." This accurately describes its nature, distinguishing it from purely benign lesions (A) or overtly malignant tumors (C, D). It is also a neoplastic process, not merely reactive (E).
Question 92
A 22-year-old female presents with a giant cell tumor located near her knee joint. Which of the following clinical symptoms is commonly associated with giant cell tumors due to their proximity to joints?
View Answer & Explanation
Correct Answer: C
Rationale: The text lists "limitation of joint motion" as one of the clinical presentations of giant cell tumors. This is consistent with their epiphyseal location near joints. The other options are not described as typical symptoms of GCT.
Question 93
A 39-year-old male presents with chronic pain and weakness in his arm, diagnosed with a giant cell tumor of the distal humerus. Which muscle-related clinical finding is commonly associated with giant cell tumors?
View Answer & Explanation
Correct Answer: C
Rationale: The text lists "regional muscle atrophy" as one of the clinical presentations of giant cell tumors. This can occur due to disuse or chronic pain associated with the lesion. The other options are not typical presentations of GCT.
Question 94
A pathologist is reviewing a biopsy specimen from a 28-year-old patient with a suspected giant cell tumor. On microscopic examination, numerous giant cells are observed. What is a crucial distinguishing feature of the giant cells in a giant cell tumor compared to the background mononuclear cells?

View Answer & Explanation
Correct Answer: B
Rationale: The text states, "The cells composing the giant cells should be similar in appearance to the background cells." This similarity is a key diagnostic feature differentiating GCT from other giant cell-rich lesions where the giant cells might be reactive and morphologically distinct from the neoplastic stromal cells. Option A describes a feature that would argue against GCT. The other options describe features not specified as distinguishing characteristics in the provided text.
Question 95
A 36-year-old male undergoes an MRI for a suspected giant cell tumor of the distal femur. The MRI includes sequences with and without contrast. Which of the following enhancement patterns is expected for a giant cell tumor?
View Answer & Explanation
Correct Answer: C
Rationale: The text states that giant cell tumors "enhance with administration of gadolinium." While the specific pattern isn't detailed as "diffuse," it implies significant enhancement throughout the lesion, consistent with its vascularity and cellularity. The other options describe absent, limited, or specific patterns not generally characteristic of GCT enhancement as per the text.
Question 96
A 45-year-old male presents with 3 months of progressive pain and swelling in his distal thigh. He denies any recent trauma. Physical examination reveals a tender, firm mass over the distal femur. Radiographs show subtle cortical thickening and a lytic lesion in the distal femur.
View Answer & Explanation
Correct Answer: B
Rationale: The clinical text states that "any bone can be affected, but most often the femur is involved." Lymphoma of bone can present at any age, not predominantly in children. Systemic symptoms are common with multifocal involvement. Radiographic findings are often subtle and permeative, not typically aggressive osteolysis with clear margins. While primary osseous lesions occur, the majority of bone lymphomas arise in nodal tissues and subsequently metastasize to bone.
Question 97
A 62-year-old woman presents with insidious onset of left knee pain. Radiographs of the distal femur show subtle lucency and cortical irregularity. Due to persistent symptoms, an MRI is ordered.

View Answer & Explanation
Correct Answer: C
Rationale: The clinical text and Fig. 8.105 state that "The size of lesion detected on MRI with lymphoma is often far greater than suggested on radiographs." Radiographic findings are often subtle and easy to overlook, while MRI reveals the true extent of marrow involvement and associated soft tissue mass. Options A and E are incorrect as MRI typically shows a much larger lesion. Option B is incorrect as a soft tissue mass is characteristic. Option D is incorrect as reactive sclerosis is not the primary finding.
Question 98
A 58-year-old male presents with diffuse bone pain, fatigue, and unexplained weight loss over the past several months. He also reports night sweats. Physical examination reveals generalized lymphadenopathy and a palpable spleen. Radiographs show multiple subtle lytic lesions in various bones.
View Answer & Explanation
Correct Answer: C
Rationale: The clinical text explicitly states, "Patients with multifocal bone involvement may complain of systemic symptoms such as malaise, night sweats, etc." and "Physical findings include a tender mass, lymphadenopathy and splenomegaly." A solitary osseous lesion is less likely to cause such widespread systemic symptoms. These symptoms are indicative of more advanced or widespread disease, not necessarily early stage. The findings are consistent with a malignant process, not benign. While a soft tissue mass can be present, the systemic symptoms and bone lesions point to lymphoma.
Question 99
A 70-year-old woman undergoes a biopsy of a permeative lesion in her proximal humerus. Histopathological examination reveals large cells with nuclear pleomorphism and moderately abundant cytoplasm. Immunohistochemistry is pending.

View Answer & Explanation
Correct Answer: C
Rationale: The clinical text, referring to Fig. 8.106, states, "Note the large cell size and the nuclear pleomorphism typically found in diffuse large B-cell lymphoma (the most common lymphoma of bone)." Hodgkin lymphoma is less common in bone and has distinct Reed-Sternberg cells. The description does not fit follicular, small lymphocytic, or mantle cell lymphomas, which typically have different cellular characteristics.
Question 100
A 55-year-old male has a biopsy of a lytic lesion in his tibia. Histology shows a lymphoreticular tumor with large, pleomorphic cells. To confirm the diagnosis and characterize the tumor, immunohistochemical staining is performed.
View Answer & Explanation
Correct Answer: D
Rationale: The clinical text states, "As these are mature B-cell tumors, they generally will stain positive for the immunohistochemical markers CD19 and CD20." S100 is typically positive in neural tumors or melanoma. CD3 is a T-cell marker. CD1a is associated with Langerhans cell histiocytosis. Desmin is a marker for muscle differentiation.
You Might Also Like